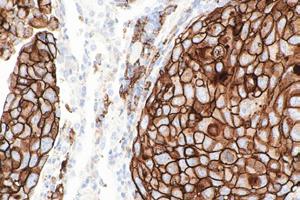

Conf. Univ. Dr. Dana Lucia Stănculeanu


UMF „Carol Davila” din București, Președinte SNOMR
Conf. Univ. Dr. Bianca Gălățeanu
Președinte Conferință OncoHub 2023








Prof. Univ. Dr. Octav Ginghină



UMF „Carol Davila” din București, Președinte Comitet Științific OncoHub 2023



Prof. Univ. Dr. Cristian Ioan Chiricuță

Centrul de Radioterapie AMETHYST, Otopeni



Șef lucrări Dr. Cristian Lungulescu
Vicepreședinte SNOMR, UMF din Craiova



As. Univ. Dr. Vecerzan Liliana


Universitatea „Lucian Blaga” din Sibiu, Facultatea de Medicină, Departamentul Preclinic


Prof. Univ. Dr. Alin Cumpănaș
Clinica de Urologie, UMF Victor Babeș, Timișoara
Prof. Univ. Dr. Alexandru Tătaru
UMF. „Iuliu Hațieganu” Cluj, Dept. Dermatologie

Revista profesioniștilor din Sănătate • 2023 - 2024 • Publicație creditată B+ conform
și Radioterapie Radioterapie / Oncologie Proton Impex 2000 SRL pharma ewo
Oncologie medicală

















































Patologia oncologică trebuie abordată personalizat, fiecare pacient este unic, ghidurile terapeutice ne îndrumă, iar experiența își spune de asemenea cuvântul! Interviu realizat cu Conf. Univ. Dr. Dana Lucia Stănculeanu 10

„Conceptul OncoHub susține sinergia dintre cercetarea științifică și practica medicală pentru accelerarea progresului în medicină!“

Interviu realizat cu Conf. Univ. Dr. Bianca Gălățeanu, Dr. Ariana Hudiță, Prof. Univ. Dr. Octav Ginghină 18

„Remodelarea” în radioterapia unor tumori mamare local avansate Chiricuță I.C., Zarma Ioana, Suditu Mihai
Reacții adverse cutanate grave ale chimioterapiei antineoplazice
Univ. Dr. Vecerzan Liliana
Diagnosticul de laborator în sindromul Lynch Dr. Oana Cristina Voinea
Angiosarcomul hepatic – prezentare de caz
As. Univ. Dr. Ana Maria Ghiuchici, Conf. Univ. Dr. Mirela Danilă, Conf. Univ. Dr. Maria Cornianu, Dr. Nicoleta


Caz rar de gastrită cu CMV imitând carcinomul gastric– prezentare de caz
As. Univ. Dr. Constantin Budin, As. Univ. Dr. Daniel Stăniloaie, Dr. Andreea Tănase, Dr. Alexandru Ilco, Dr. Tarek Ammar, Dr. Andrei Seceleanu, Dr. Raluca Petre, Dr. Anca Lăzăroiu, Dr. Diana Cîșleanu, Dr. Diana Iacob
Copierea fără acordul scris al editurii a oricăror elemente de grafică sau conținut editorial apărute în revistele editurii sunt considerate furt de proprietate intelectuală şi intră sub incidența legii.
Consultant medical: Dr. Aurora Bulbuc, medic primar Medicină de familie
Editor Calea Rahovei, nr. 266-268, Sector 5, Bucureşti, Electromagnetica Business Park, Corp 01, et. 1, cam. 4 Tel: 021.321.61.23
e-mail: redactie@finwatch.ro ISSN 2286 - 3443

4 www.revistamedicalmarket.ro Oncologie Sumar
22
30 O
Șef lucrări
Lungulescu 38 Utilitatea
Dr.
Dr. Eva Gavril 44 Îngrijirile paliative: o necunoscută în Romania? Prof. Univ. Dr. Chiricuță Ioan Cristian, Dr. Amadeo Grigorean 48 Genetica în cancerul de prostată - schimbări de paradigmă în medicina de precizie a secolului XXI Prof. Univ. Dr. Alin Cumpănaș 52 Oncodermatologie – prezent și viitor în tratament Prof. Univ. Dr. Alexandru Tătaru 58
Asis.
29
nouă eră de colaborare și inovație în oncologia românească
dr. Cristian
IHC și ISH în diagnosticul oncologic de precizie
Irina Nuca, Dr. Ștefania Brebu, Dr. Iuliu Cristian Ivanov, Dr. Roxana Popescu, Dr. Cosmin-Teodor Mihai,
Iacob,
62 Suplimentele orale nutriționale –
subiect neînțeles Dr. Irina Mateieș
Prof. Univ. Dr. Ioan Sporea
un
66
68
Testarea imunologică pentru afecțiunile tractului gastrointestinal
SENTiFIT® 270







SENTiFOB®



Sisteme automate special proiectate pentru testarea cantitativă, imunoturbidimetrică, din materii fecale
Ÿ Excluderea bolilor inflamatorii intestinale

CALia Gold Calprotectină
Măsurarea calprotectinei din materii fecale
Ÿ Screeningul pacienților asimptomatici pentru cancerul colorectal
Ÿ Testarea pacienților simptomatici cu suspiciune de hemoragie digestivă
FOB Gold Hemoragii oculte în fecale
Măsurarea hemoglobinei umane din materii fecale



































Interviu realizat cu Doamna Conf. Univ. Dr. Dana Lucia Stănculeanu, medic primar oncologie medicală și Șef Secție Oncologie Medicală 1 în Institutul Oncologic București, Președintele Societății Naționale de Oncologie Medicală din România

Care sunt actualitățile în tratamentul oncologic în 2023?
Cancerul reprezintă a doua cauză de deces după bolile cardiovasculare, atât în Europa cât și în țara noastră, reprezentând 26% din totalul deceselor. Progresele în oncologie se orientează atât spre evaluarea factorilor de risc și a metodelor de prevenire cât și spre depistarea precoce a bolii, metode noi de tratament care presupun evaluarea principalilor biomarkeri tumorali, modalități de urmărire a evoluției acestora pe parcursul bolii oncologice, evaluarea pacientului în comisii multidisciplinare atunci când discutăm stabilirea managementului bolii oncologice pe tot parcursul acesteia.
Provocările și actualitățile ultimilor 2 ani au fost date de noile tratamente, de noile molecule, în aproape toate localizările. Un exemplu important îl reprezintă cancerul de sân mai ales pentru forma triplu negativă unde mai multe molecule au dus la schimbarea completă a viziunii de tratament, dar și modalitățile de combinare între aceste molecule: imunoterapie, chimioterapie și terapiile țintite. De asemenea și abordarea secvențială a tratamentului este o nouă provocare, alături de managementul reacțiilor adverse.
Trastuzumab Deruxtecan și-a dovedit fără echivoc eficacitatea în tratamentul cancerului mamar metastatic cu expresie low HER-2 cu rezultate notabile atât pri-
vind supraviețuirea fără progresie a bolii (PFS), cât și supraviețuirea generală (OS). Trebuie să recunoaștem că acest subtip molecular privind statusul low HER2 (definit ca scor 1+ la imunohistochimie (IHC) sau 2+ la IHC și rezultat negativ la hibridizarea in situ) trebuie privit ca o entitate separată și cercetat pentru viitoare abordări terapeutice, nu doar în stadiul metastatic, cât și poate în adjuvantă. Un alt anticorp monoclonal conjugat nou apărut în scenă dacă ne referim tot la cancerul mamar triplu negativ multiplu tratat sau la pacientele cu cancer mamar nerezecabil sau metastazat cu receptori hormonali pozitivi HER2 negativi care au utilizat anterior terapie endocrină și cel puțin două terapii sistemice suplimentare este sacituzumab govitecan.
De asemenea, în ultimul an au apărut oportunități terapeutice prin aprobarea pentru decontare CNAS a multiple molecule noi care au permis abordul bolii oncologice într-o manieră modernă.
Acestea reprezintă doar câteva noutăți în tratamentul medical al bolii oncologice. Dar dacă discutăm în general despre noutăți în oncologie atunci ar trebui să dicutăm și despre metode noi de diagnostic precoce sau de metode noi de abordare chirurgicală folosind tehnici moderne cum ar fi chirurgia robotică sau microinvazivă sau tehnici noi de tratament radiologic sau metode noi de urmărire a bolnavului oncologic. Cred că
important rămâne însă și accesul la tratament care să fie cât mai echitabil astfel încât toți pacienții să poată beneficia de tratament.
Ce perspective vedeți în tratamentul cancerului prin vaccinare?
Vaccinurile împotriva cancerului reprezintă o arie emergentă și promițătoare în cercetarea medicală. Aceste vaccinuri au ca scop stimularea sistemului imunitar al pacientului pentru a identifica și ataca celulele canceroase. Există mai multe abordări diferite în dezvoltarea vaccinurilor pentru tratamentul cancerului. De menționat ar fi vaccinurile folosite în prevenția bolii, cum sunt cele împotriva infecției cu HPV sau împotriva virusurilor hepatitei.
În ultima perioadă și în România se încearcă o nouă strategie de prevenție prin vaccinare și consider că ar trebui implementate campaniile de screening și prevenție pentru afecțiunile neoplazice la nivel național.
De asemenea de menționat sunt și vaccinurile terapeutice, concepute pentru a trata pacienții care deja au cancer prin activarea sistemului imunitar pentru a recunoaște și a ataca celulele canceroase. Aceste vaccinuri pot fi personalizate pentru fiecare pacient în parte, ținând cont de specificitatea tumorii respective. Sigur aceste vaccinuri se află în faza de cerce-
10 www.revistamedicalmarket.ro Oncologie Interviu
Patologia oncologică trebuie abordată personalizat, fiecare pacient este unic, ghidurile terapeutice ne îndrumă, iar experiența își spune de asemenea cuvântul!
Analgezie multimodală eficace

şi reducere rapidă a durerii acute
Doza recomandată este de 1 comprimat filmat/1 plic cu granule pentru soluţie orală (echivalent la clorhidrat de tramadol 75 mg şi dexketoprofen 25 mg) până la maxim 3 comprimate / 3 plicuri pe zi (echivalent la clorhidrat de tramadol 225 mg şi dexketoprofen 75 mg). Intervalul minim între doze: 8 ore. Skudexa este destinat numai administrării pe termen scurt, nu mai mult de 5 zile.
1 Moore RA, McQuay HJ, Tomaszewski J, Raba G, Tutunaru D, Lietuviete N, et al. BMC Anesthesiol. 2016 ian 22; 16:9.
Studiu multicentric, randomizat, dublu-orb, cu grupuri paralele, controlat placebo si activ, cu doză unică şi doze multiple, de faza III, pe un număr de 606 paciente cu histerectomie totală sau partiala pentru afecţiuni benigne, prezentând dureri de intensitate moderată şi severă (VAS ≥ 40). Pacientele urmau să primească şapte doze consecutive din medicamentul studiului, pe o perioadă de 3 zile. Obiectivul principal de eficacitate îl reprezintă SPID8 ( suma diferentelor de intensitate a durerii la 8 h).
2 McQuay HJ, Moore RA, Berta A, Gainutdinovs O, Fülesdi B, Porvaneckas N, et al. Br J Anaesth. 2016 feb;116(2):269-76.
Studiu multicentric, randomizat, dublu-orb, cu grupuri paralele, controlat placebo şi activ, de faza III, cuprinzând o fază cu doză unică şi o fază cu doze multiple. Au fost cuprinşi 641 de pacienţi supuşi unor intervenţii standard de artroplastie totală de şold primară unilaterală pentru osteoartrită şi care acuzau în repaus dureri de intensitate cel puţin moderată (VAS ≥ 40) în ziua de după intervenţie. Medicamentul de studiu a fost administrat pe cale orală, o dată la 8h pe o perioadă de 5 zile. Obiectivul principal de eficacitate îl reprezintă SPID8 (suma diferenţelor de intensitate a durerii la 8 h).
3 Moore RA, Gay-Escoda C, Figueiredo R, Tóth-Bagi Z, Dietrich T, Milleri S, et al. J Headache Pain. 2015;16:60. Studiu multi-centric, randomizat, dublu-orb, cu grupuri paralele, controlat placebo si activ, de faza II, cu un total de 10 grupe de tratament, cu dexketoprofen trometamol (DKP [12,5 mg şi 25 mg]) şi clorhidrat de tramadol (TRAM [37,5 mg şi 75 mg]) administrate sub formă de componente unice şi în patru combinaţii fixe diferite, un grup martor activ (ibuprofen 400 mg), pe 606 pacienţi cu durere moderată şi severă (scala analog vizuală [VAS] ≥ 40 mm şi scala de evaluare verbală cu 4 puncte [VRS] ≥ 2. Obiectivul studiului a fost acela de a evalua eficacitatea analgezică superioară şi tolerabilitatea fiecărui agent unic şi a fiecărei combinaţii faţă de placebo.Obiectivul primar a fost reprezentat de proporţia pacienţilor cu cel puţin 50% din reducerea totală maximă a durerii. TOTPAR max. pe un interval de 6 ore după administrarea dozei (≥ 50% TOTPAR max).
4 Gay-Escoda C, Hanna M, Montero A, Dietrich T, Milleri S, Giergiel E, et al. BMJ Open. 2019 Feb 19;9(2):e023715. doi: 10.1136/bmjopen-2018-023715. Studiu de fază IIIb multicentric, randomizat, dublu-orb, controlat placebo şi activ, pe 653 de pacienţi sănătoşi cu vârsta de minimum 18 ani programaţi pentru extracţia pe cale chirurgicală a cel puţin unui molar 3 inferior complet sau parţial impactat. Participanţilor cu durere moderată şi severă [≥4 pe o scară de evaluare numerică (NRS) cu 11 puncte] la patru ore de la intervenţie, li s-a administrat oral o doză unică de tramadol/dexketoprofen 75 mg/25 mg (n = 260), tramadol/paracetamol 75 mg/650 mg (n = 262) sau placebo (n = 131). Obiectivul primar l-a constituit TOTPAR6 (reducerea totală a durerii la şase ore de la administrarea dozei)
5 Skudexa®, comprimate filmate, RCP, Mai 2022


6 Skudexa®, granule pentru soluţie orală, RCP, Octombrie 2022
Acest medicament se eliberează pe bază de prescripţie medicală PRF. Pentru informaţii suplimentare consultaţi RCP-ul medicamentului Acest material este destinat profesioniştilor din domeniul sănătaţii.

Analgezic opioid/AINS 5, 6 Combinaţie în doză fixă cu administrare orală 5, 6 Pentru tratamentul pe termen scurt al durerii acute moderate până la severe 5, 6
1, 2, 3, 4 RO_SKU-10-2021_V1_Adv Data pregătirii materialului Oct 2021
Tel/Fax +4021 232 34 32 / 233 08 26 www.berlin-chemie.ro
Berlin-Chemie A. Menarini Calea Floreasca 169A, Etaj 7, Sector1, Bucureşti
tare. Cercetarea în domeniul vaccinurilor pentru tratamentul afecțiunilor oncologice este în continuă evoluție și este o arie care merită exploatată și consider că în următoarea perioadă vom avea rezultate promițătoare.
Mai este astăzi imunoterapia o cale de tratament obligatoriu aplicată pacientului oncologic?
În ultimele decenii, cunoștințele noastre privind relația dintre cancer și sistemul imun au crescut considerabil. Succesul din ultimii ani privind imunoterapia în tratamentul cancerului, inclusiv anticorpii monoclonali, vaccinurile împotriva cancerului și terapia inhibitori cu puncte de control imun au revoluționat terapia antineoplazică. Imunoterapia a devenit o componentă semnificativă a tratamentului pentru aproape toate tipurile de cancer. Eficiența și utilizarea imunoterapiei variază în funcție de diverși factori precum tipul de cancer, stadiul bolii, prezența receptorilor pentru inhibitorii punctelor de control, răspunsul imunitar al pacientului și alte tratamente anterioare sau concomitente. Discutăm de mai multe tipuri de imunoterapie. Unele dintre ele sunt deja aplicate în strategia terapeutică altele sunt în curs de cercetare. Principalele tipuri sunt utilizarea inhibitorilor punctelor de control, terapia cu CART, terapia cu cytokine sau anticorpi monoclonali. Cu toate acestea, provocări încă există în acest domeniu. Terapiile combinate personalizate vor fi următoarele strategii terapeutice în oncologie, iar o cercetare atentă a interacțiunii dintre tumoră și micromediul tumoral este necesară în această direcție.
Decizia de a utiliza imunoterapia ca parte a tratamentului pentru un pacient oncologic depinde de evaluarea individuală a situației medicale și de consultul medicului oncolog. Este important ca pacientul să discute cu echipa medicală pentru a înțelege opțiunile de tratament disponibile și pentru a lua o decizie informată și personalizată.
Care considerați că este rolul Geneticii medicale în managementul multidisciplinar şi personalizat al pacientului oncologic?
Genetica medicală joacă un rol esențial în managementul multidisciplinar și
personalizat al pacienților oncologici. De la evaluarea riscului genetic și consiliere genetică până la alegerea terapiei personalizate, medicul genetician este vital în stabilirea conduitei terapeutice și trebuie să ne obișnuim să integrăm activitatea sa în echipa multidisciplinară. Sigur că pentru noi în România integrarea geneticianului în echipa multidisciplinară este la început, dar în orice activitate există un început.
Care considerați că este legătura între caracteristicile moleculare ale cancerului şi tratamentul personalizat?
Patologia oncologică trebuie abordată personalizat, fiecare pacient este unic, ghidurile terapeutice ne îndrumă, iar experiența își spune de asemenea cuvântul. Abordarea terapeutică în oncologie trebuie realizată personalizat, în funcție de profilul pacientului: clinic, biologic, molecular. Legătura dintre caracteristicile moleculare ale cancerului și tratamentul personalizat este esențială în dezvoltarea unei abordări eficiente și precise în tratarea bolii. Este crucial în înțelegerea și tratarea cancerului identificarea specifică a modificărilor moleculare și genetice care duc la dezvoltarea și progresia bolii. Caracteristicile moleculare ale cancerului, cum ar fi mutațiile genetice, anomaliile cromozomiale, exprimarea genelor și nivelurile de proteine, pot varia semnificativ între pacienți și tipuri de cancer. Aceste caracteristici moleculare joacă un rol-cheie în determinarea modului în care se dezvoltă boala, a răspunsului la tratament și evoluției în timp. Tratamentul personalizat sau tratamentul individualizat se referă la adaptarea terapiei în funcție de caracteristicile moleculare specifice ale unui pacient și ale cancerului său. Acest lucru implică o abordare precisă și direcționată comparativ cu tratamentele generice, standard.
În România există posibilități terapeutice pentru toate tipurile de cancer prin terapii țintite, imunoterapie sau combinații ale acestora. Consider că în perioada următoare se vor realiza multe descoperiri pe acest plan și posibilitățile terapeutice vor fi multiple.
În concluzie, legătura dintre caracteristicile moleculare ale cancerului și tratamentul personalizat reprezintă o paradigmă promițătoare pentru îmbună-
tățirea eficacității tratamentului și pentru reducerea efectelor secundare nedorite. Aceasta necesită utilizarea tehnologiilor de diagnostic avansate, cum ar fi secvențierea genetică și analizele moleculare, pentru a furniza informații precise și relevante pentru deciziile terapeutice.
Cum se configurează azi echipa de suport al pacientului oncologic?
Configurarea echipei de suport pentru pacienții oncologici poate varia în funcție de fiecare instituție medicală și resursele disponibile. Totuși, o echipă de suport bine configurată pentru pacienții oncologici ar trebui să includă următorii specialiști:
1. Medic oncolog: este medicul care supraveghează întregul tratament oncologic al pacientului, de la diagnostic la planificarea terapiei și monitorizarea acestuia.
2. Medic familie: are un rol important în furnizarea îngrijirilor continue, în coordonarea între diferiți specialiști și în gestionarea altor condiții medicale preexistente.
3. Asistent medical: asistenții medicali pot asista în administrarea tratamentelor, în monitorizarea efectelor secundare și în oferirea de îngrijiri de bază în cadrul clinicilor sau al spitalului.
4. Specialistul de organ: chirurg, sau oricare altă specialiate legată de tipul de tumoră a pacientului.
5. Psiholog/psihoterapeut: psihologul și/sau psihoterapeutul specializat în oncologie poate oferi suport emoțional, consiliere și tehnici de gestionare a stresului deoarece diagnosticul de cancer poate genera stres, anxietate și depresie.
6. Nutriționist: nutriția joacă un rol crucial în menținerea stării de sănătate a pacienților oncologici. Un nutriționist specializat în oncologie poate oferi sfaturi și planuri personalizate pentru a asigura aportul corect de nutrienți.
7. Sprijin confesional atât pentru pacient cât și pentru familie. Sigur, în această echipă poate fi inclus atunci când resursele permit și terapeutul fizic/reabilitare, terapeutul ocupațional sau voluntari din organizațiile non-profit. Este important de menționat că aceasta este o listă generală și că, configurarea echipei de suport poate varia în funcție de nevoile individuale ale pacienților, de
12 www.revistamedicalmarket.ro Oncologie Interviu
PUNÂND ÎN PRACTICĂ NOILE GHIDURI ESMO PRIVIND CAȘEXIA ASOCIATĂ CANCERULUI
Noile Ghiduri de Practică Clinică (CPG) ale Societății Europene de Oncologie Medicală (ESMO) au fost publicate pentru a avertiza profesioniștii din domeniul sănătății, în special tinerii oncologi, cu privire la procesul complex al cașexiei asociate cancerului și pentru a furniza recomandări standard pentru depistarea, diagnosticul și tratamentul pacienților cu cașexie manifestă, precum și a acelora aflați la risc1
Start
Define
Tube feeding
Exercise
Provide access to exercise especially muscle strength and endurance training
If oral feeding is insufficient, tube feeding is the next choice.
& manage- Screening ment of dysphagia
Diet & ONSs
First choice is dietary counselling for nutritional support. ONSs as adjunct to dietary counselling
Acknowledge the GLIM definition of malnutrition
Cancer Cachexia Management Cycle
Energy: 25-30 kcal/kg BW/day
Protein: 1.2 g/kg BW/day
Fat: Half of the non-protein calories
Nutritionalrequirement
Multi-disciplinaryteam
Include nurses, dietician, physiotherapist & psychologist in the cancer care team
Create awareness among patients & families with tailored communication
Screen and monitor all cancer patients regularly
Perform comprehensive assessment of modifiable factors Offer personalised, multitargeted treatment approaches
Treatment decision
Malnutrition diagnosis according to GLIM definition2,3

Communication
Screening Assessment
Soluțiile nutriționale potrivite ajută la maximizarea potențialului terapiei oncologice. Noul Forticare Advanced este o formulă enterală orală cu densitate nutrițională ridicată, bogată în proteine, Omega-3 și vitamina D, dezvoltată pentru pacienții cu -sau la risc de- cașexie.
1. Arends, J. et al. Cancer cachexia in adult patients: ESMO Clinical Practice Guidelines. ESMO Open 6, (2021).
2. Cederholm, T. et al. GLIM criteria for the diagnosis of malnutrition - A consensus report from the global clinical nutrition community. J Cachexia Sarcopenia Muscle 10, 207–217 (2019).
3. Cruz-Jentoft, A. J. et al. Sarcopenia: revised European consensus on definition and diagnosis. Age Ageing 48, 16–31 (2019).
Pentru mai multe informații, vizitați www.nutricia-med.ro





Conținut destinat profesioniștilor din domeniul sănătății. Forticare Advanced este un aliment destinat unor scopuri medicale speciale notificat la INSP și se utilizează sub supraveghere medicală. Nutricia, Nutricia Advanced Medical Nutrition și Danone Specialized Nutrition sunt mărci ale Danone Group. Danone P.D.P.A., Str. Soldat N. Cânea nr. 140-160, sect. 2, Bucureşti, România, Tel.: 021.242.4525 • Telverde: 0800 672 888 • e-mail: contact@nutricia-med.ro
 Scanați pentru kit-ul complet!
Scanați pentru kit-ul complet!
disponibilitatea resurselor și de specificul instituției medicale. Toate aceste aspecte sunt prezentate în PNCC.
Ce paşi sunt parcurşi în integrarea unui registru național al pacienților oncologici?
Integrarea unui registru național al pacienților oncologici implică o serie de pași complexi și etape importante pentru a asigura colectarea, gestionarea și utilizarea corectă a datelor legate de pacienții care suferă de afecțiuni oncologice. O privire generală asupra principalilor pași tipici în acest proces include: planificarea și stabilirea obiectivelor, crearea infrastructurii, stabilirea protocoalelor de colectare a datelor, colectarea datelor, asigurarea calității acestora, confidențialitate și securitate, analiza datelor, comunicarea rezultatelor și apoi monitorizarea și îmbunătățirea continuă.
De asemenea, Registrele Naționale pot colabora între ele sau pot fi extinse pentru a include și alte tipuri de afecțiuni sau grupuri de pacienți. Aceasta poate contribui la dezvoltarea unei perspective mai complete asupra sănătății populației.
O astfel de inițiativă necesită colaborarea strânsă între autoritățile de sănătate, instituțiile medicale, cercetători și profesioniști IT pentru a asigura o colectare și utilizare eficientă a datelor. Așa cum bine cunoașteți deși există reglementat din 2008 RNC practic nu a funcționat. Au funcționat doar registre regionale cum este cel de la IOCN sau cum este cel al oncopediatriei, dar nu și unul național. Datele pe care le avem și le folosim sunt cele ale GLOBOCAN care sunt date extrapolate. Noutatea este reprezentată de înființarea RNC prin Hotărârea 663/2023 publicată în Monitorul Oficial Partea I în 4 August 2023. Cred că Digitalizarea și realizarea unor programe informatice conforme stau la baza succesului realizării registrului Național de Cancer.
Există un plan național de cercetare în bolile oncologice?

Multe țări dezvoltă și implementează planuri naționale de cercetare în bolile oncologice pentru a aborda problema cancerului la nivel de populație. Aceste planuri pot include obiective precum
îmbunătățirea prevenirii, diagnosticării și tratamentului cancerului, promovarea cercetării clinice, sprijinirea cercetării fundamentale în domeniul oncologiei, dezvoltarea de tehnologii avansate de diagnostic și terapie, precum și furnizarea de resurse pentru susținerea pacienților cu cancer și a familiilor acestora.
În țara noastră sigur că există multiple programe de cercetare în marea lor majoritate la nivelul instituțiilor de învățământ, respectiv universități, institute de cercetare fie ca programe de cercetare clinică sau fundamentală. În marea lor majoritate sunt programe Europene sau intercontinentale multinaționale. Studii clinice internaționale multicentrice efectuate fie prin programele UE sau diverselor grupuri de studii. Rezultatele sunt accesibile atunci când încerci să te informezi asupra unei probleme.
Ceea ce este nou pentru țara noastră este că această problemă este prevăzută în Planul Național de Combatere a Cancerului. Probabil că în curând vor apărea Normele care vor reglementa Planul Național de cercetare.
14 www.revistamedicalmarket.ro Oncologie Interviu



Cepheid GeneXpert® Systems

Analizor RT-PCR complet automat: extracție, amplificare,detecție
Rapid și sigur: rezultate PCR în mai puțin de o oră pentru majoritatea testelor
Design compact și scalabil
Tehnologie tip cartuș: risc redus de contaminare, acces random, testare mix-and-match.
Panel teste Oncologie & Genetică
Biomedica Medizinprodukte Romania SRL 020335 Bucharest • B-dul Dimitrie Pompeiu nr. 5-7, Sector 2 • T +40 37 276 68 44 www.bmgrp.ro
Cod produs Denumire produs Impachetare GXBCRABLP190-CE-10 Xpert® BCR-ABL Ultra p190 10 teste/kit GXBCRABL-10 Xpert® BCR-ABL Ultra (p210) 10 teste/kit GXBCSTRAT4-CE-10 Xpert® Breast Cancer STRAT4 10 teste/kit GXBLAD-CD-CE-10 Xpert® Bladder Cancer Detection 10 teste/kit GXBLAD-CM-CE-10 Xpert® Bladder Cancer Monitor 10 teste/kit GXNPM1-CE-10 Xpert® NPM1 Mutation 10 teste/kit GXFIIFV-10 Xpert® FII & FV 10 teste/kit
• • •
•
ELITe InGenius® este o soluție ușor de utilizat, de la probă la rezultat, dedicată exibilitate fără precedent și o posibilitate de meniu de analiză.
ELITe InGenius® procesează 1 până la 12 mostre în piste paralele și independente.
ELITe InGenius® oferă laboratoarelor o capacitate de meniu nelimitată, combinând cel mai mare meniu de boli infecțioase CE-IVD disponibil pe un instrument de la probă la rezultat.
Oncohematology

Biomedica Medizinprodukte Romania SRL 020335 Bucharest • B-dul Dimitrie Pompeiu nr. 5-7, Sector 2 • T +40 37 276 68 44 www.bmgrp.ro
Healthcare Associated Infec tions MRSA/SA S. aureus mecA/mecC CRE KPC IMP/VIM/NDM OXA 48 ESBL C T X-M-1/15 C T X-M-9/14 Toxin A Toxin B Colistin/R mcr1 mcr2
BCR-ABL P210 RNA REFERENCE BCR-ABL P190 COAGULATION FactorV Factor II MTHFR C677T APOE CYP2C9-2 CYP2C9-3 HLA-B27 HLA-B5701 Lactose Intolerance LCT - 13910C/T MTHFR A1298C BETA-FIBRINOGEN MTHFR C677T FACTOR V H1299R FACTOR XIIIV34L HFE C282Y HFE H63D HFE S65C HPA-1 A/B PAI-1 4G/5G VKORC1 MTRR A66G MTR A2756G AML1-ETO (8;21) CBFb-MYH11
PML-RARA t(15;17) FACTOR V Y1702C
Genetics
(inv16)
Interviu realizat cu Conf. Univ. Dr. Bianca Gălățeanu - Facultatea de Biologie a Universității din București, Președinte Conferință OncoHub 2023, Prof. Univ. Dr. Octav Ginghină - UMF „Carol Davila” din București, Președinte Comitet Științific OncoHub 2023, Dr. Ariana Hudiță - Facultatea de Biologie a Universității din București Președinte Comitet de Organizare OncoHub 2023

Conferinţa OncoHub - Connecting Physicians & Scientists for Next Generation Cancer Management a ajuns la cea de a treia ediţie şi va avea loc anul acesta în format hibrid, în perioada 20-22 Septembrie 2023 la Bucureşti. Care sunt conceptul şi obiectivele Conferinţei?
de cercetare-inovare, (iii) evidențierea celor mai noi tehnologii și abordări biomedicale în domeniul oncologiei, și nu în ultimul rând, (iv) formarea noilor generații de specialiști prin accesul la instrumente educaționale moderne. Astfel, conceptul OncoHub, susține sinergia dintre cercetarea științifică și practica medicală pentru accelerarea progresului în medicină, cu accent pe medicina de precizie și abordarea personalizată a pacienților.
Organizați pentru prima dată un eveniment pre-congres. Ce v-a determinat să faceți acest lucru şi în ce va consta el?
în cadrul acestui eveniment pre-congres oferim și un simpozion de radioterapie în care se va evidenția potențialul inteligenței artificiale în acest domeniu. Aceste simpozioane vor fi susținute de fondatorii OncoHub, împreună cu echipele lor, care s-au alăturat acestui proiect.
Prevenţia joacă un rol esenţial în diagnosticarea precoce şi tratarea cât mai complexă a patologiei cancerului. Cum aţi defini multidisciplinaritatea medicală respectiv rolul tumor board-ului?

Conferința OncoHub își propune să creeze o platformă care să faciliteze interacțiunea dintre cercetători și profesioniști din domenii biomedicale, medici și industrie pentru identificarea unor soluții inovative în beneficiul pacienților oncologici. Acest HUB multidisciplinar are ca obiective: (i) crearea unor direcții de cercetare cu aplicabilitate clinică imediată, (ii) identificarea de noi oportunități de colaborare pentru inițierea unor clustere
Ideea acestui simpozion a existat încă de la începutul proiectului OncoHub și suntem bucuroși că anul acesta am găsit resursele necesare pentru a-l pune în practică. Acest eveniment a fost gândit ca ,,o călătorie” care începe în sala de operație și se termină în laboratorul de cercetare, pentru a sublinia importanța colaborării dintre medici și cercetatori printr-o experiență unică și cât se poate de reală. Astfel, participanții vor avea oportunitatea de a vedea o tehnică chirurgicală modernă în cancerul colorectal avansat și de a asista la un protocol de procesare semiautomatizată a țesutului excizat. După caracterizarea prin citometrie în flux a probei procesate, participanții vor identifica impactul rezultatelor asupra modulării imunoterapiei pacienților. Nu în ultimul rând, în era transformării digitale,
Prin componenta multidisciplinară a echipei, tumor board-ul reunește expertiza diferitelor specialități medicale precum: chirurgia, radiologia, oncologia, radioterapia, patologia medicală,
18 www.revistamedicalmarket.ro Oncologie Interviu
„Conceptul OncoHub susține sinergia dintre cercetarea științifică și practica medicală pentru accelerarea progresului în medicină!“
Conf. Univ. Dr. Bianca Gălățeanu
Dr. Ariana Hudiță










etc., pentru a dezvolta un plan eficient și personalizat de abordare a fiecărui pacient oncologic. Astfel, conturarea unei strategii integrate de management al pacientului de la diagnostic și până la recuperare poate îmbunătăți semnificativ atât prognosticul cât și calitatea vieții. Pentru a evidenția importanța existenței acestor tumor board-uri în practica medicală românească, propunem o masă rotundă, chiar în prima zi a conferinței, care va simula un astfel de tumor board pentru abordarea modernă a cancerului de rect.


Cum au contribuit proiectele dumneavoastraă de cercetare pentru dezvoltarea unor noi metode de prognostic şi modulare a terapiei în cancer?

Una dintre preocupările actuale în sfera oncologiei este dezvoltarea unor metode minim invazive de monitorizare recurentă/continuă a pacientului oncologic cu potențial de a identifica prognosticul, de a modula terapia în timp real și/ sau de a identifica boala minimă reziduală. Pentru aceasta, fluidele biologice ușor accesibile, cum ar fi sângele de exemplu, au fost intens studiate de cercetători din întreaga lume pentru a se identifica markeri circulanți cu potențial de a oferi informații relevante. Astăzi știm că aceste ,,biopsii lichide” permit medicilor să analizeze o serie de informații despre fenotipul și genotipul particular al tumorii unui pacient dintr-o simplă probă de sânge periferic. Din 2016 și până în prezent echipa noastră multidisciplinară de cercetare a contribuit la dezvoltarea unor protocoale pentru biopsie lichidă prin implementarea a trei proiecte de cercetare finanțate din fonduri naționale de cercetare. În tot acest timp am studiat metode de izolare și caracterizare a celulelor tumorale circulante și am dezvoltat protocoale de analiză a ADN tumoral circulant prin secvențiere de nouă generație (NGS - Next Generation Sequencing) pentru a identifica mutații în sângele pacienților cu cancer de colon, sân sau pulmonar. Prin rezultatele obținute și publicate, proiectele noastre au contribuit doar la dezvoltarea unor noi analize cu impact major asupra prognosticului și a modulării terapiei la pacienții cu patologii oncologice în stadii avansate. În plus, prin crearea unor consorții între mediul academic, spitale și clinici private am consolidat implicarea mediului privat

în dezvoltarea cercetării fundamentale cu un impact major asupra stimulării inovării. Nu în ultimul rând, un număr semnificativ de pacienți au beneficiat gratuit de analize genomice avansate și de monitorizare în cadrul proiectelor noastre de cercetare.
prelevării tumorii și nu oferă o viziune dinamică asupra evoluției clonale ce poate duce de cele mai multe ori la modificări genomice semnificative ce se traduc prin dezvoltarea unor mecansime de rezistență la schema de tratament administrată. Având în vedere aceste elemente cheie în biologia cancerului, caracterizarea în timp real a profilului celulelor tumorale reprezintă o monitorizare cu un real potențial în modularea răspunsului la tratament. Astfel, biopsia lichidă și în mod special, analiza ADN circulant tumoral prezintă un imens potențial ca biomarker în terapia personalizată a pacienților cu cancere avansate, deoarece el poartă semnătura genetică a celulelor tumorale din care provine.
Ce proiecte de cercetare biomedicalăîn domeniul oncologiei urmează să elaboraţi?
Cu ce ajută monitorizarea în timp real a profilului molecular al pacienţilor pentru îmbunătățirea prognosticului şi a răspunsului la terapie?
Protocolul actual de stabilire a unei scheme terapeutice se bazează pe rezultatele unei biopsii de țesut, însă această abordare nu are în vedere potențialul imens al tumorilor de a-și modifica caracteristicile. Astfel, dacă privim biopsia de țesut ca pe o imagine punctuală/statică, ea oferă o informație limitată asupra profilului molecular tumoral. Această informație se referă doar la momentul
Caracterizarea micromediului tumoral, adică a tuturor componentelor dintr-o tumoră, și în special analiza infiltratului limfocitar, prezintă un imens potențial în modularea trapiei imune la pacienții cu anumite tipuri de cancer. Cu toate că aceste aspecte sunt deja cunoscute în lumea științifică și medicală, preocupările noastre actuale se canalizează pe identificarea unor mecanisme acționabile în vederea ajustării acestui micromediu tumoral în sensul creșterii eficienței imunoterapiei. O altă preocupare constantă în grupul nostru de cercetare este dezvoltarea unor nanotransportori care să crească eficiența tratamentelor oncologice și să scadă semnificativ efectele adverse sistemice resimțite de pacienți.
20 www.revistamedicalmarket.ro Oncologie Interviu
Prof. Univ. Dr. Octav Ginghină
Easypump® II
Easypump® II
Terapie în mișcare pentru pacienţii dumneavoastră!
Terapie în mișcare pentru pacienţii dumneavoastră!
SISTEM DE POMPĂ ELASTOMERICĂ PENTRU PERFUZIE
SISTEM DE POMPĂ ELASTOMERICĂ PENTRU PERFUZIE
PE TERMEN SCURT SAU LUNG
PE TERMEN SCURT SAU LUNG
Dispozitiv medical
Clasa de risc IIb
Producator: B. Braun Melsungen AG Germania
Dispozitiv medical Clasa de risc IIb
Citiţi cu atenţie instrucţiunile de utilizare
Producator: B. Braun Melsungen AG Germania
Citiţi cu atenţie instrucţiunile de utilizare
Acest material este dedicat exclusiv profesioniștilor din domeniul sănătăţii. Pentru raportarea evenimentelor adverse vă rugăm să utilizaţi urmatoarele date de contact: +40722591065/+40723550017 sau Email: pharmacovigilance.ro@bbraun.com
Acest material este dedicat exclusiv profesioniștilor din domeniul sănătăţii. Pentru raportarea evenimentelor adverse vă rugăm să utilizaţi urmatoarele
date de contact: +40722591065/+40723550017 sau Email: pharmacovigilance.ro@bbraun.com
www.magazin-bbraun.ro | www.bbraun.ro | contact.ro@bbraun.com | https://www.facebook.com/bbraunRO/
www.magazin-bbraun.ro | www.bbraun.ro | contact.ro@bbraun.com | https://www.facebook.com/bbraunRO/
Easypump® II este acum gata pentru a fi conectată la dispozitivul de acces vascular al oricărui pacient. Pastraţi Easypump® II în Borseta pentru transport în cazul în care conectarea nu se face imediat.
Easypump® II este acum gata pentru a fi conectată la dispozitivul de acces vascular al oricărui pacient. Pastraţi Easypump® II în Borseta pentru transport în cazul în care conectarea nu se face imediat.




HC/0323/213_1
HC/0323/213_1
„Remodelarea” în radioterapia unor tumori mamare local avansate
Abstract. Progresele realizate în aplicarea radiațiilor au făcut posibile noi abordări pentru cancerul local avansat. Procesul de „remodelare” este acum o realitate, iar vindecarea locală a tumorii local avansate doar prin radioterapie cu doze mari este acum posibilă. Pe baza tehnicilor moderne de iradiere, cum ar fi IMRT de tip VMAT, Rapid Arc sau Tomoterapie, distribuția dozei conform cu forma volumului tumoral și aplicarea de doze totale mari a făcut posibil procesul de „remodelare” la nivelul țesuturilor moi. Vă prezentăm din propria noastră experiență rezultatul radioterapiei a două tumori mamare local avansate pentru care a fost obținut clinic un control tumoral. Acest lucru a fost posibil datorită aplicării de doze curative de 70 – 72 Gy. În aceste cazuri a fost obținut un control tumoral cu refacerea structurilor invadate. Acest proces de refacere este definit ca „REMODELING“. Etapele vindecării și efectele radioterapiei la nivelul țesutului tumoral și peritumoral (tumor microenvironment – TME) sunt descrise.
Zarma Ioana,
Suditu Mihai
Centrul de Radioterapie
AMETHYST, Otopeni, România
Tratamentul pacienților cu cancer mamar local avansat este un subiect mult dezbătut în ultimele decenii. La sfârșitul ultimului deceniu, tratamentul complex a inclus intervenții chirurgicale radicale, ca amputarea sânului, chirurgia plastică reparatorie, chimioterapia și radioterapia. Toate aceste intervenții erau însoțite și de efecte secundare accentuate. Noi concepte au putut fi dezvoltate datorită progreselor în metodele de diagnostic, în caracterizarea tumorii și în progresul aplicării tratamentului (chirurgical conservativ sau radioterapie cu doze mari) pentru cancerul mamar local avansat.
Vă prezentăm aici evolutia clinică a două cancere mamare local avansate și explicităm procesul de “vindecare” în aceste cazuri, definit ca “remodeling” până la refacerea membranei bazale.
Procesul de vindecare
și de reparare a țesuturilor afectate tumoral
Complexitatea „vindecării” după intervenția chirurgicală și procesul de reparare a țesuturilor după radioterapie cu repre-

zentarea celor 4 faze ale vindecării (hemostază, fază inflamatorie, faza proliferativă și faza de remodeling) care se suprapun parțial este prezentată în figura de mai jos.
Etapele procesului de vindecare după intervenția chirurgicală și radioterapie cu suprapunerea lor parțială (pe scara timpului): hemostază, fază inflamatorie, proliferarea și remodelarea țesuturilor cu acumularea de colagen în fază terminală. (Maynard J. Cum se vindecă rănile: cele patru faze principale ale vindecării rănilor. Shield Health Care 2015).


Aspecte clinice
Aceste cazuri demonstrează capacitatea de „remodelare” care există la nivelul țesutului sănătos peritumoral atunci când
“Remodelarea” prin radioterapie: sus – tumoră cu infiltrarea membranei bazale și a structurilor adiacente: jos – distrugerea tumorii și refacerea membranei bazale (linia groasă roșie).
tumora primară este iradiată cu o doza totală mare și cu o fracționare ce permite controlul tumoral și nu produce efecte secundare la nivelul organelor și structurilor cu risc crescut la doza aplicată. În acest caz, acțiunea de vindecare a fost inițiată și completată de activitatea macrofagilor și stimularea fibroblaștilor prezenți la acest nivel cu rol și în limitarea efectelor secundare. Acțiunea fibroblaștilor a contribuit la procesul
22 www.revistamedicalmarket.ro Articole de specialitate Oncologie
Chiricuță I.C.,
ale procesului de „REMODELARE“ prin exemplificarea pacientelor noastre
Radioterapia transformatoare nu face numai progrese, ci face diferența.







Sistemul de radioterapie Halcyon™ a fost construit pentru a transforma modul în care lumea gândește despre lupta împotriva cancerului. Cu un flux de lucru intuitiv, precizie ghidată imagistic și timp de tratament redus, Halcyon oferă mai multe oportunități de a oferi mai multă îngrijire mai multor pacienți, deoarece noile victorii în lupta împotriva cancerului contează acum mai mult ca niciodată.


















Pentru a afla mai multe despre inovația noastră transformatoare, vizitați Varian.com/halcyon









Informații de siguranță: Radiațiile pot provoca efecte secundare și pot să nu fie adecvate pentru toate tipurile de cancer.

© 2018-2023 Varian Medical Systems, Inc. Varian și Varian Medical Systems sunt mărci comerciale înregistrate, iar Halcyon este o marcă comercială a Varian Medical Systems, Inc.
Articole de specialitate
de remodelare cu un rezultat final favorabil. Astfel, a fost posibilă „remodelarea” la acest nivel a tuturor structurilor implicate inițial în procesul tumoral. Efectele secundare acute la nivelul pielii au fost reduse.
În procesul de vindecare, rolul macrofagelor este de îndepărtare a celulelor tumorale deteriorate prin lezarea bi-catenară la nivelul ADN-ului tumoral. În aceste cazuri, a fost sesizat un proces de fibroză limitat la nivelul patului tumoral. Reacțiile postradice s-au vindecat complet.
Planul de iradiere a pacientei din cazul nr. 2 a fost efectuat la secția de fizică medicală din Centrul de Radioterapie Amethyst din Otopeni.
Cazurile noastre:
1. Tumoră mamară la o pacientă în vârstă de 82 de ani (iradiere efectuată în anul 1997)
Cazurile noastre:
2. Tumoră mamară la o pacientă în vârstă de 87 de ani
Planul de iradiere a fost executat după efectuarea unei examinări CT și delimitarea volumelor țintă și optimizarea planului de iradiere, cu aplicarea dozei dorite la nivelul tumorii mamare local avansate cu implicarea tuturor țesuturilor până la rebordul costal.
Evoluția din timpul radioterapiei externe. Înainte de inițierea radioterapiei externe (stânga), cu planul de iradiere aplicat (în mijloc – cu roșu Volumul Țintă iradiat) și după finalizarea radioterapiei. Aplicați au fost 72 Gy.
Evoluția clinică de la începutul radioterapiei și după terminarea ei este redată în figura de mai sus.




Evoluția din timpul radioterapiei externe. Înainte de inițierea radioterapiei externe (stânga), cu planul de iradiere aplicat (în mijloc) și după finalizarea ra-
În literatura de specialitate sunt indicate în cazul tumorilor mamare local avansate regimuri de iradiere cu doze paliative extrem de diferite (10 x 3 Gy, 20 x 2 Gy, 25 x 2 Gy). Noi am aplicat doze curative de 70 -72 Gy.
În concluzie: Progresul în radioterapie este rezultatul îmbunătățirii metodelor imagistice (CT, RMN, PET / CT) și a metodelor realizate în calculul planului de iradiere și de aplicare a iradierii. Tehnicile moderne de radioterapie sunt toate bazate pe intensitatea modulată a fascicolelor (IMRT), ca de exemplu: VMAT (volume modulated arc therapay), Rapid Arc și Tomoterapie. La AMETHYST RADIOTHERAPY CENTER, standardul nostru este administrarea dozei optime la nivelul bolii microscopice (CTV) și macroscopice (GTV) și administrarea unei doze limitate la nivelul organelor cu risc crescut la iradiere, cum a fost în cazul unui cancer mamar local avansat,. Controlul local al tumorii cu efecte secundare acute și tardive reduse fac acum posibilă îmbunătățirea calității vieții acestor pacienți care sigur în alte clinici nu sunt iradiați cu doze locale curative.


24 www.revistamedicalmarket.ro
Oncologie
dioterapiei. Aplicați au fost 70 Gy.
Pentru centrul Amethyst Cluj, anul 2023 a venit cu noi schimbări, menite să îmbunătățească calitatea tratamentelor oferite pacienților cu un diagnostic oncologic. Astfel că, de la instalarea unor noi aparate mai moderne, până la mărirea echipei medicale, prin angajarea unor noi membrii, clinica Amethyst Cluj a continuat să pună pacientul pe primul loc și să se dezvolte, pentru a oferi cele mai bune tratamente din România.
Despre clinicile Amethyst
Rețeaua Amethyst România face parte din lanțul european Amethyst, fiind cea mai mare rețea de centre care oferă radioterapie și tratamente oncologice din Europa. Povestea a început cu deschiderea centrului Amethyst Otopeni în anul 2012, urmând apoi deschiderea clinicii din Cluj, în anul 2014. Amethyst a fost printre primele centre care au pus bazele radioterapiei moderne în România, oferind servicii și tratamente care, până în acel moment, reprezentau un standard în Europa de Vest, însă care nu erau disponibile la noi în țară. Din acel moment, centrele au cunoscut o dezvoltare continuă, îmbunătățind constant calitatea tratamentelor oferite. Acest lucru s-a realizat, în primul rând, prin aparatură. În radioterapie, precizia și poziționarea corectă a pacientului este o condiție esențială în succesul tratamentului, iar pentru asta, centrul Amethyst Cluj dispune de sisteme de poziționare moderne, cu ajutorul cărora reușim să administrăm un tratament țintit și precis pacienților. Mai mult decât atât, în cadrul clinicii Amethyst Cluj există două acceleratoare liniare identice, care oferă continuitate tratamentului, lucru extrem de important pentru pacienții care trebuie să se prezinte la tratament zilnic.
Pe lângă radioterapia clasică, cu ajutorul instalației de tratament MicroSelectron Digital Afterloader cu 18 canale și sursă radioactivă HDR Iridium 192, produs de Nucletron Nederland, sunt oferite servicii de radioterapie internă în cadrul laboratorului de brahiterapie.
Printre cele mai noi și moderne tehnici de tratament utilizate, se regăsește radioterapia stereotactică, care reprezintă un standard de tratament în anumite tipuri de cancer, dar și tehnica Deep Inspiration Breath Hold. Cea din urmă este cea mai performantă tehnologie care previne toxicitatea inimii pentru pacientele cu cancer la sânul stâng, dar și pentru pacienții cu tumori pulmonare. Anul acesta, pe lângă instalarea unui nou aparat de Computer Tomograf mai performant decât cel precedent, Clinica Amethyst Cluj vine cu un nou serviciu decontat, disponibil pentru toți pacienții clinicii și nu numai: imagistică medicală de tip RMN, cu ajutorul aparatului de ultimă generație Magnetom Sola RT Pro
Edition Siemens Healthineers, fiind primul RMN dedicat simulării pentru radioterapie din România.
Clinica Amethyst Cluj oferă, de asemenea și tratamente de oncologie medicală, astfel că și medicii din cadrul acestui departament fac parte din comisia multidisciplinară. În cadrul acestor întâlniri zilnice, se stabilește schema de tratament personalizată în funcție de nevoile fiecărui pacient.
Totodată, pacienții, beneficiază atât de consiliere psihologică, cât și nutrițională, astfel tratamentul oncologic efectuat în Clinica Amethyst, este unul complex și oferă pacientului tot ceea ce are nevoie pentru a înfrunta un asemenea diagnostic.
Echipa Amethyst
Dezvoltarea brandului Amethyst nu a însemnat niciodată doar aparatură de ultimă generație, întotdeauna au existat cel puțin două componente, echipa și aparatura.
Din dorința ca pacienții să primească tratamentul necesar la momentul potrivit, în cadrul echipei Amethyst Cluj s-au alăturat doi colegi noi, doamna doctor Palyi Kiss Emoke - medic specialist oncologie medicală, cât și domnul doctor Claudiu Hopîrtean, medic primar radioterapie, specializat în radioterapia stereotactică.
Planuri de viitor
Misiunea Amethyst este de a trata pacienții oncologici la standarde europene cât mai aproape de casă. Așadar, recent au fost deschise centrele din județele Timiș și Alba, iar în anul 2024 se vor mai deschide încă două centre Amethyst, în țară.
Date de contact:
021.9368; office.cluj@amethyst-radiotherapy.com Strada Răzoare, 486G, Florești, Jud. Cluj
Radioterapie / Oncologie
ALUNBRIG® (BRIGATINIB) A ÎNREGISTRAT
33,2
DURATA MEDIANĂ DE RĂSPUNS CU ALUNBRIG
LA RESPONDENŢII CONFIRMAŢI VERSUS 13,8 LUNI CU CRIZOTINIB1
Referinţe: 1. Camidge DR, Kim HR, Ahn MJ, Yang JCH, Han JY, Hochmair MJ, Lee KH, Delmonte A, Garcia Campelo MR, Kim DW, Griesinger F, Felip E, Califano R, Spira AI, Gettinger SN, Tiseo M, Lin HM, Liu Y, Vranceanu F, Niu H, Zhang P, Popat S. Brigatinib Versus Crizotinib in ALK Inhibitor-Naive Advanced ALK-Positive NSCLC: Final Results of Phase 3 ALTA-1L Trial. J Thorac Oncol. 2021 Dec;16(12):2091-2108. doi: 10.1016/j.jtho.2021.07.035. Epub 2021 Sep 16. Erratum in: J Thorac Oncol. 2022 Oct 14;: PMID: 34537440. 2. ALUNBRIG - Rezumatul Caracteristicilor Produsului – ultima versiune aprobată - iulie 2023
INDICAŢII TERAPEUTICE:
ALUNBRIG® este indicat în monoterapie pentru tratamentul pacienţilor adulţi cu cancer pulmonar non-microcelular (NSCLC) avansat, ALK pozitiv, care nu au fost trataţi anterior cu un inhibitor de ALK.2
ALUNBRIG® este indicat în monoterapie pentru tratamentul pacienţilor adulţi cu NSCLC avansat, ALK pozitiv, trataţi anterior cu crizotinib.2

Acest material promoţional este destinat profesioniștilor din domeniul sănătăţii. Pentru informaţii medicale suplimentare vă rugăm să contactaţi medinfoemea@takeda.com
Caracteristicilor Produsului
O PRELUNGIRE A MEDIANEI PFS DE PESTE
ORI MAI MARE VERSUS CRIZOTINIB*1
3
Grafic adaptat conform referinţa Camidge DR.
30,8 luni(1 (IC 95%: 21,3-40,6)
ALUNBRIG®
Crizotinib
0 6 ALUNBRIG® 137 102 88 78 70 60 52 30 3 12 18 24 30 36 42 48 54 0,0 0,2 0,4 06 0,8 10 P r obabilitatea P F S Crizotinib 138 80 46 35 22 18 17 7 1 Luni Nr. la risc
9,2 luni1 (IC 95%: 7,4-12,7) C-APROM/RO/ALUN/0058, septembrie, 2023
(n=137)1
(n=138)1
Mediana PFS conform analiză investigator1
LA PACIENŢII DIN POPULAŢIA CU INTENŢIE DE TRATAMENT
luni
*Conform analizei investigatorilor1 CI, interval de confidenţă; HR, rata de hazard; PFS, supravieţuirea fără progresia bolii; ITT, cu intenţie de tratament.
TAKEDA PHARMACEUTICALS S.R.L Piața Presei Libere, Nr. 3-5, Et. 15, Clădirea City Gate Turn SUD, Aripa Dreaptă Sector 1, București Tel: +40213350391, Fax: +40213350394
Scanaţi codul QR pentru Rezumatul
ÎN TRATAMENTUL MIELOLUMUL MULTIPLU R/R, NINLARO® OFERĂ
EFICACITATE DE DURATĂ
PROFIL DE SIGURANȚĂ FAVORABIL
IP = inhibitor de proteazom; Rd = lenalidomidă și dexametazonă; R/R = recăzut/refractar; *versus Rd.
Referinţe:
1. Rezumatul caracteristicilor produsului NINLARO – accesat în septembrie 2023
2. P. Moreau, T. Masszi, N. Grzasko N Engl J Med 2016;374:1621-34.
Înainte de a prescrie Ninlaro, vă rugăm să citiți Rezumatul caracteristicilor produsului accesând codul QR alăturat
Acest medicament face obiectul unei monitorizări suplimentare. Acest lucru va permite identificarea rapidă de noi informaţii referitoare la siguranţă. Profesioniştii din domeniul sănătăţii sunt rugaţi să raporteze orice reacţii adverse suspectate.

Pentru informaţii medicale suplimentare vă rugăm să contactaţi medinfoemea@takeda.com
Acest material promoţional este destinat profesioniștilor din domeniul sănătăţii.
*2
C-APROM/RO/NINL/0087 Septembrie 2023
Takeda Pharmaceuticals SRL Piața Presei Libere nr. 3-5, Clădirea City Gate, Turn Sud, Aripa Dreaptă, Etajul 15, Sector 1, OP 013702, București, România, tel: +40 21.335.03.91; fax: +40 21.335.03.94
NINLARO® este indicat în asociere cu lenalidomină și dexametazonă, pentru tratamentul pacienţilor adulţi cu mielom multiplu care au urmat cel puţin un tratament anterior.1
ADCETRIS este indicat pentru pacienții adulți cu:1
• Limfom Hodgkin (LH) CD30+ stadiul IV, netratat anterior, în asociere cu doxorubicină, vinblastină și dacarbazină (AVD)
• Limfom Hodgkin (LH) CD30+ care prezintă risc crescut de recidivă sau progresie după transplant de celule stem autologe (TCSA)

• Limfom Hodgkin (LH) CD30+ recidivat sau refractar:
1. după TCSA, sau
2 după cel puțin două tratamente anterioare, când TCSA sau chimioterapia cu mai multe medicamente nu reprezintă o opțiune de tratament.
• Limfom anaplazic cu celule mari sistemic (LACMs) netratat anterior, în asociere cu ciclofosfamidă, doxorubicină si prednison (CHP)
• Limfom anaplazic cu celule mari sistemic (LACMs) recidivat sau refractar
• Limfom cutanat cu celule T (CTCL) CD30+ după cel puțin 1 tratament sistemic anterior
Pentru informații medicale suplimentare vă rugăm să contactați medinfoemea@takeda.com Acest material promoțional este destinat profesioniștilor din domeniul sănătății.
Înainte de a prescrie Adcetris, vă rugăm să citiți Rezumatul caracteristicilor produsului accesând codul QR alăturat
Takeda Pharmaceuticals SRL Piața Presei Libere nr. 3-5, Clădirea City Gate, Turn Sud, Aripa Dreaptă, Etajul 15, Sector 1, OP 013702, București, România, tel: +40 21.335.03.91; fax: +40 21.335.03.94
C-APROM/RO/ADCE/0074 Septembrie 2023
1.ADCETRIS, Rezumatul Caracteristicilor Produsului.
Reacții adverse cutanate grave ale chimioterapiei antineoplazice
Terapia chimioterapică antineoplazică poate provoca o serie de modificări la nivelul tegumentelor, mucoaselor și fanerelor. Când apar leziuni dermatologice la pacienții în tratament cu chimioterapice antineoplazice, acestea pot reprezenta un efect secundar al terapiei, dar trebuie luate în considerare și alte cauze. Acestea includ o hipersensibilitate cutanată la alte medicamente administrate concomitent, exacerbarea unei afecțiuni existente anterior, infecții, metastazarea tumorilor la nivel cutanat, sindroame paraneoplazice, boala grefă contra gazdă sau toxiinfecții alimentare. Diagnosticul precis și managementul tratamentului efectelor adverse legate de chimioterapice, necesită cunoașterea de către medicul curant a celor mai frecvente tipuri de reacții adverse cutanate raportate medicamentelor pe care le primește pacientul. De asemenea, medicul trebuie să fie familiarizat cu manifestările cutanate ale anumitor tipuri de neoplazii, precum și cu efectele adverse cutanate postchimioterapie [1]
Oserie de agenți chimioterapici antineoplazici pot provoca reacții adverse cutanate care pun viața în pericol, cum ar fi sindromul Stevens-Johnson/necroliza epidermică toxică (SSJ/NET) și reacție indusă medicamentos însoțită de eozinofilie și afectare sistemică (DRESS).
Asemănările din constatările clinice și histopatologice între SSJ și eritemul multiform pot determina la o clasificare greșită a SSJ limitată ca eritem multiform în puținele cazuri publicate; astfel că erupția în SSJ/ NET debutează, de obicei, cu mici bule care apar pe fondul unor macule violacee și cu leziuni atipice, plate, „în țintă”, iar una dintre caracteristici este necroza extinsă și detașarea epidermei din cauza apoptozei masive a keratinocitelor, predominând, de obicei, la nivelul trunchiului. Severitatea sa este legată de procentul de suprafață corporală implicată, variind de la mai puțin de 10% în SSJ până la mai mult de 30% în NET. Febra și leziunile hemoragice ale mucoaselor apar în ambele tipuri de afecțiuni. SSJ/NET sunt, în majoritatea cazurilor, declanșate de medicamente. Inițial, pacientul poate prezenta disestezie. Leziunile buloase se dezvoltă rapid, adesea în 12 ore, atât la nivel tegumentar, cât și la nivelul mucoaselor. Mortalitatea este mare și depinde, în general, de vârsta
pacientului și extinderea decolării cutanate. Din punct de vedere al prognosticului, este important momentul în care a fost întreruptă administrarea medicamentului; perioada de latență dintre inițierea tratamentului și debutul erupției pentru SSJ/NET este între 4 zile și o lună, dar se poate extinde până la 2 luni pentru medicamentele cu un timp de înjumătățire mai lung [2] .
Deși mecanismele patogenetice ale SSJ/ NET sunt incomplet înțelese, una dintre ipoteze este faptul că Celulele T citotoxice CD8, specifice medicamentului, împreună cu celulele natural killer (NK), sunt inductori majori ai apoptozei keratinocitelor. Printre diferitele proteine și citokine citotoxice (ligandul solubil Fas, perforină/granzimă, factor de necroză tumorală-alfa) implicate în apoptoza extinsă a keratinocitelor, granulizina, o proteină citolitică găsită în celulele T citotoxice și celulele NK, par să joace un rol cheie.
Majoritatea pacienților cu SSJ/NET necesită internare și instituirea unui tratament de specialitate, din cauza afectării extensive tegumentare cu risc de deshidratare și sepsis. Se justifică întreruperea imediată și permanentă a medicamentului. Pacienții care dezvoltă SSJ/NET nu ar trebui să fie niciodată reexpuși la medicamentul incriminat din cauza riscului de recidivă fatală.
Mai mulți agenți chimioterapici au fost asociați cu apariția SSJ/NET, printre care cei mai uzuali, enumerăm: Docetaxel, Paclitaxel, Gemcitabină, Temozolamida, Capecitabină, Doxorubicină, Pemetrexed, Cetuximab, Imatinib.
DRESS este o reacție de hipersensibilitate indusă medicamentos, rară; ce
pune viața în pericol, care se prezintă cu o erupție cutanată, anomalii hematologice (eozinofilie, limfocitoză atipică), limfadenopatie și/sau afectarea organelor (ficat, rinichi, plămâni). Câțiva agenți antineoplazici au fost asociați cu DRESS, inclusiv clorambuci și lenalidomidă [1]
La majoritatea pacienților, reacția începe la două până la șase săptămâni după inițierea medicamentului incriminat. Debutează cu o erupție morbiliformă care progresează mai mult sau mai puțin rapid spre un eritem difuz, confluent și infiltrat. 60 până la 80% dintre pacienți, au afectare hepatică. Identificarea și retragerea promptă a medicamentului este principalul tratament pentru pacienții cu DRESS.

Concluzii
Determinarea cauzalității medicamentului la pacienții cu cancer poate fi dificilă, din cauza utilizării frecvente a unor scheme terapeutice ce utilizează mai mulți agenți chimioterapici în combinație și a utilizării concomitente a altor medicamente pentru a trata condițiile și comorbiditățile asociate. În plus, pacienții cu cancer pot avea un risc crescut de SSJ/ NET din cauza malignității în sine.
Referințe:
1. Payne A.S, Savarese D, Cutaneous side effects of conventional chemotherapy agents, Uptodate, 2019, Acesat: în 19.11.2022, https://www.uptodate.com/ contents/cutaneous-side-effects-of-conventional-chemotherapy-agents?source=history_widget
2. Brockow, K, Ardern-Jones, MR, Mockenhaupt, M, et al. EAACI position paper on how to classify cutaneous manifestations of drug hypersensitivity. Allergy. 2019; 74: 14– 27. https://doi.org/10.1111/all.13562
29 Articole de specialitate Oncologie 2023 - 2024
Asis. Univ. Dr. Vecerzan Liliana
Universitatea „Lucian Blaga” din Sibiu, Facultatea de Medicină, Departamentul Preclinic
Diagnosticul de laborator în sindromul Lynch
Sindromul Lynch reprezintă cea mai frecventă patologie genetică ereditară ce se manifestă printr-o predispoziție crescută cu până la 80% comparativ cu populația generală de a dezvolta leziuni maligne, cu debut la vârstă tânără, cu precădere de la nivelul tubului digestiv și aparatului genital.
sindrom sunt lipsite de caracteristici specifice. Din acest motiv, este esențială evaluarea IHC a statusului MMR sau prin tehnici PCR a statusului MSI sau MSS.
• Pierderea PMS2 este adesea asociată cu pierderea MLH1 și este semnificativă în mod independent numai dacă MLH1 este intact.
Diagnosticul precoce reușește, în urma unui consult genetic, prin programe particularizate de screening, să identifice leziunile, când apar, în stadii incipiente de boală, având ca rezultat, o speranță de viață apropiată cu cea a populației generale.
Defectul genetic caracteristic este reprezentat de variante patogene ale sistemului MMR, care are ca funcție principală repararea ADN-ului când acesta este replicat greșit. Aceste gene sunt cunoscute, respectiv MLH1, MSH2, PMS2, MSH6, EPCAM și pot fi identificate prin alterări în expresia imunohistochimică, precum și prin apariția unor fragmente patogene, denumite microsateliți, decelabili prin tehnica PCR.
Diagnosticul sindromului Lynch este ghidat clinic prin criteriile Amsterdam II și Bethesda revizuite, însă puterea lor de a identifica pacienți este perfectibilă. Multe carcinoame asociate cu sindromul Lynch sunt observate la pacienți care nu îndeplinesc criteriile Bethesda sau Amsterdam în istoricul personal/familial pentru sindromul Lynch.
Cele mai recente ghiduri recomandă testarea universală a tumorilor de colon și uneori endometru, prin teste IHC pentru decelarea dMMR sau PCR, pentru identificarea statusului MSI.
Caracteristicile histopatologice care sugerează carcinomul asociat sindromului Lynch sunt bine caracterizate în colon - localizarea proximală, carcinoame mucinoase, cu celule în inel cu pecete, slab diferențiate, cu bogat infiltrat inflamator intratumoral, adesea agregate limfoide Crohn-like, dar nu la fel de bine în endometru, deși se pare că mai frecvent sunt endometrioide, cu localizare în 1/2 inferioară a corpului uterin. Specificitatea acestor trăsături histopatologice, observabile în colorația Hematoxilina-Eozina (HE) este limitată, iar alte carcinoame care apar în acest
Studiile demonstrează că sensibilitatea și specificitatea testelor IHC sunt superpozabile celor prin PCR, cu o concordanță apreciată de NCCN de 99%.
Conform ghidurilor NCCN, ar trebui să existe o testare universală a carcinoamelor endometriale prin tehnica IHC a MMR/sau prin tehnica PCR pentru instabilitatea microsatelitară (MSI).
• Analiza hipermetilării MLH1 ar trebui finalizată pe tumorile care arată pierderea MLH1 pe IHC pentru a ajuta la trierea cazurilor adecvate pentru testarea liniei germinale.
Potențiale surse de eroare ale rezultatelor pot fi reprezentate de timpul de ischemie rece (timpul petrecut dintre prelevarea tumorii și prelucrarea de laborator), erori de fixare (în special pe piesele de histerectomie, de aceea se preferă analiza pe prelevatele biopsice) sau tratamente anterioare (pentru tumorile de rect radiotratate) precum și echipamente sau consumabile neconforme.
Figura 1. Algoritmul de diagnostic pentru probele de carcinom colorectal sau

MMR (prin IHC) sau MSI (prin PCR) sunt biomarkeri cu rol DIAGNOSTIC, PROGNOSTIC ȘI PREDICTIV:
• Diagnostic: 15% din CCR pot fi MMRd/ MSI-H, majoritatea fiind de origine somatică
• Prognostic: mai bun comparativ cu cele MMRp/MSI-L (demonstrate pentru stadiile II și III)
• Predictiv - răspuns mai redus la 5FU; răspuns bun la imunoterapie
Diagnosticul pozitiv pentru instabilitate microsatelitară, prin tehnici de PCR, returnează rezultate pozitive, de tipul MSI-H, dacă apar aceste fragmente în procesul de secvențiere.

Testarea MMR prin imunohistochimie este efectuată pe țesut încorporat în parafină și compară rezultatele ADN-ului tumoral cu cele ale țesuturilor neoplazice de la același pacient.
• Pierderea exprimării MSH2 sau MSH6 indică în esență întotdeauna sindromul Lynch. Carcinomul endometrial asociat sindromului Lynch este asociat predominant cu mutațiile MSH2 și mutații MSH6.
Pentru rezultate optime, echipamentele precum și consumabilele de laborator au nevoie de standarde înalte de calitate acreditate.
Testarea genetică este indicată în toate cazurile de rezultate anormale, însă chiar și în prezența unor rezultate negative, dacă pacientul are un istoric personal sau familial important de patologie neoplazică ori are cancere cu debut la vârstă tânără ori cancere multiple.
Societatea Română de Sindrom Lynch are ca principal obiectiv optimizarea managementului diagnostic, terapeutic și de screening, motiv pentru care susține testarea universală a cancerelor de colon și endometru.

Pentru detalii suplimentare accesați pagina www.srsl.ro sau iar dacă doriți să ne contactați, ne găsiți la adresa contact@srsl.ro
Toate informațiile din acest articol au fost preluate din Ghidul Introductiv în Sindrom Lynch pentru medici. Dacă doriți să intrați în posesia lui, solicitați-l pe adresa de mail contact@srsl.ro iar noi vi-l vom livra în format fizic fără niciun cost!
30 www.revistamedicalmarket.ro Articole de specialitate Oncologie
endometrial.
Dr. Oana Cristina Voinea
MD PhD Medic Primar Anatomie Patologică Președinte Fondator SRSL



Malnutriția și cașexia pot fi cauzate atât de boala oncologică,
cât și de terapia acesteia1,4-13
REDUCEREA APORTULUI
i NUTRIȚIONAL e, anorexie, ogic,sihol g durer reață, Cauze:vărsături,disgeuz s e, mala tres pbsorbție
MALNUTRIȚIA
Până la 67% din pacienții oncologici au niveluri reduse de vitamina D, iar pănă la 31% sunt afectați de deficiență 10,11
Până la 70% din pacienții cu cancer suferă de alterarea gustului în timpul chimioterapiei și radioterapiei7
NEVOI METABOLICE CRESCUTE


catabolsitemică
s




ea cs uze: cr , eșter i on sm în exce umului s, Ca energeticflainmația
Inflamația sistemică poate afecta >50% din pacienții cu cancer, și este mai prevalentă în stadiile avansate13
• Perturbarea metabolismului proteic, cu creșterea proteolizei în mușchii scheletici și scăderea sintezei de masă musculară
• Pierdere de masă corporală slabă și scăderea parametrilor funcțional
• Cașexie, indusă de pierderile proteice, pierderile de lipide și anorexie
• Deprimarea funcției sistemului imun și creșterea riscului de infecții
Inflamația sistemică accelerează ciclul malnutriție-cașexie - chiar în etapele terapeutice în care este foarte importantă asigurarea unei stări nutriționale adecvate4
Malnutriția și cașexia afectează eficacitatea terapiei oncologice și prognosticul pacienților 15-29
Reducerea toleranței la terapia oncologică15,16
Riscul de reacții adverse severe este crescut
Creșterea riscului de infecții, postchirurgical sau în timpul chimio-/radioterapiei17-22
>5x
Creșterea riscului de complicații postoperatorii21-23
Creșterea duratei de spitalizare și a ratelor de reinternare a paciențior17,22 - 26
la pacienții cu masă musculară scăzută și/sau coeficient scăzut de atenuare CT a masei musculare, aflați sub imunoterapie15
În majoriatea tipurilor de cancer, toxicitatea limitatoare de doză este mai frecventă la pacienții sarcopenici28
Doar 1 din 2 pacienți oncologici care suferă de malnutriție primesc suport nutrițional29
ȘI CAȘEXIA
Pentru mai multe informații, vizitați www.nutricia-med.ro Conținut destinat profesioniștilor din domeniul sănătății. Forticare Advanced este un aliment destinat unor scopuri medicale speciale notificat la INSP și se utilizează sub supraveghere medicală. Nutricia, Nutricia Advanced Medical Nutrition și Danone Specialized Nutrition sunt mărci ale Danone Group. Danone P.D.P.A., Str. Soldat N. Cânea nr. 140-160, sect. 2, Bucureşti, România, Tel.: 021.242.4525 • Telverde: 0800 672 888 • e-mail: contact@nutricia-med.ro
Tube feeding
Exercise
Provide access to exercise especially muscle strength and endurance training
If oral feeding is insufficient, tube feeding is the next choice. & manage- Screening ment of dysphagia
Diet & ONSs
First choice is dietary counselling for nutritional support. ONSs as adjunct to dietary counselling
Define
Acknowledge the GLIM definition of malnutrition
Cancer Cachexia

Management Cycle
Energy: 25-30 kcal/kg BW/day
Protein: 1.2 g/kg BW/day

Fat: Half of the non-protein calories
Nutritionalrequirement
Include nurses, dietician, physiotherapist & psychologist in the cancer care team
Multi-disciplinaryteam Communication
Create awareness among patients & families with tailored communication
Screen and monitor all cancer patients regularly
Perform comprehensive assessment of modifiable factors Offer personalised, multitargeted treatment approaches
Assessment
Screening
Treatment decision
Soluțiilenutriționalepotriviteajutălamaximizareapotențialuluiterapiei oncologice,prinîmbunătățireastăriinutriționaleapacienților




NoulForticareAdvanced-soluțiaenteralăoralăcudensitatenutriționalăridicată,bogatăînOmega-3, dezvoltatăpentrupaciențiicu,saulariscde,malnutrițieasociatăcancerului



Densitateproteicăși energeticăridicată,pentru atingereațintelornutriționale
HIPERPROTEIC, HIPERCALORIC 306kcal306kcal șiși 18 g protein18proteine
Acizigrașipolinesaturațicu proprietățiantiinflamatorii,, cu cuununefectbeneficîn efectbeneficîn inflamațiinflamațiaasistemicsistemicăă
ÎMBOGĂȚIT CUACIZI GRAȘI ωω-3DIN ULEIDEPEȘTE
1.1 g EPA1.1EPA și 00..7 g D7DHHAA
Pentruprevenirea aparițieideficienței devitaminaD
71%dintrepaciențiicu disgeuzieaupreferat gustulplăcut,răcoritor, alaromelorForticare Advanced30
COMPACT (125ml)ȘI
SPECIALIZATE, 3030
Pentrucreșterea complianței,aderențeiși experiențeipacientului
7. Spotten et al. Ann Oncol. 2017;28(5):969-84. 8. Nejatinamini, et al. Nutr Cancer. 2017;70(3):474-82. 9. Nejatinamini, et al. Nutrients. 2018;10(9): 1236. 10. Churilla, et al. BMJ Open. 2011;1(2):e000397. 11. Ströhle, A et al Onc Rep. 2010;24(4):815-28. 12. Mardas, et al. Supp Care Cancer. 2015;24(6):2619-25. 13. Muscaritoli, et al. Oncotarget. 2017;8(45):79884-79896. 14. Ethun, et al. Ca Cancer J Clin. 2017;67:362-37. 15. Andreyev, et al. Eur J Cancer. 1998;34(4):503-9. 16. Daly, et al. Pro Nutr Soc. 2018;77:135-51. 17. Marshall, et al. Clin Nutr. 2018;38(2):644-51.

D a D
CONFORM GHIDURILOR ESPENȘIESPENȘI ESMO 1,2
18. Fukuda, et al. Ann Surg Onc. 2015;22(3):S778-85. 19. Lieffers, et al. Br J Cancer. 2012;107(6):931-6. 20. Zheng, et al. Ann Surg Onc. 2017;24(11):3376-85. 21. Zhao, et al. Nutr Cancer. 2018;70(8):1254-1263. 22. Pressoir, et al. Br J Cancer.2010;102(6):966-71. 23. Na, et al. Nutr Cancer. 2018;70(8):1228-36. 24. D’Almeida, et al. J Nutr Health Aging. 2020;24:166-71. 25. Loan, et al. Nutrition. 2018; 48:117-121. 26. Zhang, et al. J Geriatric Onc. 2019;10(6):874-83. 27. Ryan, et al. Nutrition. 2019;67-68:110539. 28. Daly, et al. Br J Cancer. 2017; 116(3):310-17. 29. Hebuterne, et al. JPEN. 2014;38(2):196-204. 30. Nutricia: data on File.
1. Arends, et al. Clin Nutr. 2017;36(1):11-48. 2. Arends, et al. ESMO Clinical Practice Guidelines. ESMO Open 2021. 3. Calder, et al. Biochem Biophys Acta. 2015;185(4):469-84. 4. Fearon, et al. Lancet Onc. 2011;12(5):489-95. 5. Baracos, et al. Nat Rev Dis Primers. 2018;4. 6. Argilés, et al. Nat Rev Cancer. 2014;14(11):754-62.
Valori
sticlă de
ml Conținut destinat profesioniștilor din domeniul sănătății. Forticare Advanced este un aliment destinat unor scopuri medicale speciale și se utilizează sub supraveghere medicală.
CCooooll
ManManggoo P Peeacachh CCooooll BBerrerryy
nutriționale per
125
RECOMANDĂRILE ESMO PRIVIND CAȘEXIA 1
Audit RTSafe
- Pregătire în vederea certificării ISRS -

Certificarea ISRS demonstrează implementarea celor mai bune practici în ceea ce privește selecția pacienților, planificarea tratamentului, dozimetria și îngrijirea pacientului în SRS intracranian.
Colaborarea cu RTsafe va ajuta la pregătirea departamentului pentru Certificarea ISRS și va demonstra angajamentul dumneavoastra față de îngrijirea pacientului la cea mai înaltă calitate.
ACCURIS MEDICAL SRL distribuitor autorizat RTSafe office@accuris.ro Download the reference DATASET Follow the SRS treatment steps Send back the dosimeters Receive Prime phantom with the dosimeters Upload the plan Data Obtain dosimetry and detailed evaluation report
Noul Sistemde poziționare All-In-One Y-Series Meicende la RENFU MEDICAL



Noul Sistem de poziționare All-In-One Y-Series Meicen de la RENFU MEDICAL
Head & Shoulder Chest- Pelvic



• Placa de bază din fibră de carbon HQ
• Placa de bază din fibră de carbon HQ
• Mul�ple tratamente, inclusiv SRS și SBRT
• Multiple tratamente, inclusiv SRS și SBRT
• Configurat dual pentru adulți ș i pediatrie
• Configurat dual pentru adulți și pediatrie
• Compa�bil cu măș � Pin -Lock S-type

• Compatibil cu măști Pin-Lock S-type
• Compa�bil cu Elekta IGUIDE Frame


• Compatibil cu Elekta IGUIDE Frame
• Poziționare precisă și confort pentru pacient
• Poziționare precisă și confort pentru pacient MEICEN
Quality · Service · Harmony · Innova�on
- SOLUȚII DE POZIȚIONARE ÎN RADIOTERAPIE DE LA RENFU MEDICAL ACCURIS MEDICAL SRL distribuitor autorizat RENFU MEDICAL office@accuris.ro
Y- Series AIO Baseplate Solutions
Quality · Service · Harmony · Innovation
MEDICAL office@accuris.ro
MEICEN - SOLUȚII DE POZIȚIONARE ÎN RADIOTERAPIE DE LA RENFU MEDICAL
ACCURIS MEDICAL SRL distribuitor autorizat RENFU
SCREENING CANCER PULMONAR DIN PROBE DE SÂNGE



SĂNĂTATEA TA CONTEAZĂ! Acordă-ți o șansă! Află dacă ești bine! EARLYCDT®
imunologic pentru screeningul cancerului pulmonar
Test
Test non invaziv pentru screening și monitorizare a pacienților cu cancer de vezică.
Simplu De încredere Rapid
proba: URINĂ

valoare predictivă negativă
 PENTRU MAI MULTE DETALII SCANEAZA AICI
PENTRU MAI MULTE DETALII SCANEAZA AICI
O nouă eră de colaborare și inovație în oncologia românească

Dacă ar trebui să aleg două cuvinte prin care să caracterizez generația mea de oncologi, îmi vin imediat în minte „perseverență“ și „unitate“. Am descoperit aceste lucruri pe parcursul a trei ani de Forum Științific al Tinerilor Oncologi, ani în care am pornit de la zero cu o inițiativă și am ajuns la o comunitate de oncologi dedicați, muncitori, cu abilități și resurse interne pe care nu le bănuiam în noi.
putut adapta în mediul online, acestea au fost anulate. Pentru medicul oncolog tânăr, care nu avusese foarte multe oportunități să își creeze o rețea profesională solidă, acest lucru însemna izolare.
România, din păcate, se confruntă cu o lipsă acută de medici specializați în oncologie. Numărul mic de specialiști în raport cu numărul de pacienți duce la suprasolicitarea acestora, la burnout profesional și la monopolizarea resurselor. Astfel, un tânăr rezident sau specialist, angrenat constant în practica clinică, își găsește cu greu timpul și resursele necesare să interacționeze cu alți tineri oncologi, cu ultimele noutăți și inovații. Acest lucru devine cu atât mai greu în contextul în care nu ai un cadru sau o platformă care să te ajute.

Forumul Științific al Tinerilor Medici Oncologi a luat naștere din dorința unui grup restrâns de specialiști tineri de a crea un cadru în care să poată ieși din ,,bula” lor și să dezvolte relații profesionale solide, atât cu alți specialiști din țară, cât și cu medici tineri din afara țării. Ideea evenimentului a primit un sprijin covârșitor din partea Consiliului Director al Societății Naționale de Oncologie Medicală din România, sub egida căreia se desfășoară anual.
Nevoia unui astfel de eveniment a venit în contextul pandemiei Covid-19, în care stresul și izolarea creșteau din ce în ce mai mult. Practica clinică, ce venea deja cu greutățile de zi cu zi, a devenit, dintr-o dată, aproape imposibilă. Evenimentele medicale pre-pandemie, care se desfășurau în mare parte în format fizic, au fost luate pe nepregătite și, în situațiile în care nu s-au
Ideea organizării unui eveniment, de către tineri oncologi pentru tineri oncologi, a venit ca un suflu nou. Chiar dacă lucrurile se întâmplau în proporție de 90% în mediul online, rotițele comunicării, puse atunci în mișcare, nu au mai putut fi oprite și mașinăria a crescut de la an la an. Tinerii specialiști și rezidenții au descoperit că pot avea o voce, că au idei și, de cele mai multe ori, ideile sunt comune. Au realizat că, lucrând împreună, pot realiza lucruri pe care nu le puteau face singuri înainte sau că acum le pot face mai rapid sau cu rezultate mai bune. Au devenit mai încrezători ca profesioniști din domeniul medical și au intrat în legătură cu alți tineri specialiști din afara țării.
Sună ușor când pui lucrurile pe hârtie, însă, în realitate, a fost un proces care s-a
desfășurat pe parcursul a trei ani, în care s-a construit încet, pentru că încrederea profesională se construiește anevoios, în timp. Este nevoie de angajamente duse la capăt și colaborări productive pentru ca semenii tăi să creadă și să înceapă să simtă că sunt parte integrantă din această nouă comunitate de oncologi.
Forumul a însemnat și o schimbare la 180 grade în mentalitatea tinerilor. Dintr-o dată nu li se mai spunea ce și cum trebuie să facă, ci erau provocați să se gândească la modul în care cred ei că trebuie să se întâmple lucrurile. Astfel, de la an la an, s-au adăugat noi sesiuni interesante, foarte apreciate de participanți. Pe lângă lucrările științifice, Forumul a creat un spațiu de discuții deschise și constructive despre provocările și oportunitățile din domeniul oncologiei în contextul medical actual. Este foarte important să existe o conștientizare și o validare a provocărilor cu care ne confruntăm zi de zi, este important ca un tânăr specialist să știe că
38 www.revistamedicalmarket.ro Articole de specialitate Oncologie
Șef lucrări dr. Cristian Lungulescu
Vicepreședinte Societatea Națională de Oncologie Medicală din România, UMF din Craiova
Forumul Științific Național al Tinerilor Medici Oncologi, ediția a-III-a, 18-20 Mai 2023, Sibiu
SISTEMUL DE TERAPIE
CU PROTONI RADIANCE 330

• oferă tratament de terapie cu protoni de ultimă generație, cu precizia scanării cu fascicul de creion și puterea imagisticii integrate.
• are cea mai mică amprentă de sincrotron de pe piață.
Sincrotrotronii au un număr redus de neutroni secundari și radiații de dispersie, ceea ce reduce riscul de radiații inutile și nedorite pentru pacient și pentru instalație.

• capacitatea de 330 MeV face ca R330
să fie singurul sistem de pe piață capabil să realizeze imagistica oricărei zone a corpului.
Proton Impex 2000 SRL
63, Trilului Street, 030401 Bucharest; Tel/Fax: +40.21.224.5281;
E-mail: office@proton.com.ro
Website: http://proton.com.ro
www.imagisticamedicala.ro
www.shimadzumedical.ro
DOZATOR AUTOMAT DE CITOSTATICE PHARMODUCT

Cititor de bare intern pentru identificarea flacoanelor de medicamente introduse manual de către utilizator; Reconstituire automată a medicamentelor;
Doza este verificată în timp real cu ajutorul unei scări gravimetrice; Sortare automată a flacoanelor goale; Printare automată a etichetelor personalizate;
Dozare în mediu steril;
Sistem de decontaminare cu ozon; Pompe peristaltice pentru transferul lichidelor; Până la 35 de dozări/oră;
Eroare globală sub 5%; Identifică peste 300 de medicamente.
Proton Impex 2000 SRL
nu este singurul care trece prin experiențe care l-ar putea afecta negativ, însă cel mai important este să realizeze că poate avea în spate o rețea de oameni asemănători de la care poate primi suport.
După primele două ediții ale Forumului Științific al Tinerilor Medici Oncologi a devenit tot mai evidentă nevoia consolidării acestui cadru și în afara celor trei zile de eveniment. Astfel, Divizia Tinerilor Oncologi Români a apărut organic în cadrul Societății Naționale de Oncologie Medicală. Deși aspirațiile medicilor oncologi pentru îmbunătățirea condițiilor tratamentului pacienților sunt comune la orice vârstă, nevoile generației tinere sunt diferite față de cele ale oncologilor experimentați. La fel, și oportunitățile de care beneficiază un oncolog experimentat sunt diferite de cele pe care le poate accesa un medic la început de drum.
Conducerea actuală a Societății Naționale de Oncologie Medicală este foarte bine conectată la aceste realități și încearcă în mod constant să creeze pentru membrii Societății programe de care să beneficieze indiferent de vârstă sau grad profesional, dar și unele construite ținând cont de nevoi specifice. Astfel, a existat un sprijin consecvent pentru constituirea Diviziei Tinerilor Oncologi și pentru a oferi un anumit grad de independență în gestionarea activităților diviziei.
În acest moment, nucleul organizației de tineret s-a mărit la un grup de aproximativ 50 de medici specialiști și rezidenți, dornici să colaboreze și să își asume noi inițiative. Pe lângă efortul colaborativ pe care îl depun pe tot parcursul anului pentru organizarea Forumului Științific Național al Tinerilor Medici Oncologi, această comunicare constantă a facilitat noi colaborări
între membrii Diviziei. Astfel, în grupuri mai mici sau mai mari, colegii oncologi colaborează la scrierea articolelor academice, pentru publicarea cărora beneficiază de sprijinul financiar al Societății Naționale de Oncologie Medicală din România.
rea nevoii de a înființa o divizie pentru tineret în interiorul societății. „Sunt mândră să afirm că tinerii oncologi au un rol crucial în această revoluție în domeniul oncologiei. Prin energia și entuziasmul lor, sunt înzestrați cu o viziune proaspătă


Un alt proiect de viitor pe care SNOMR dorește să îl implementeze pentru ramura tânără a asociației este reprezentat de un program de burse de merit care să le permită membrilor să acceseze programe de schimb de experiență cu centre medicale de renume din afara țării. Aceste burse sunt menite să acopere costurile de trai pentru 6 luni, astfel încât beneficiarul să se poată concentra pe acumularea cât mai multor experiențe și informații benefice pentru cariera sa de medic oncolog.
Conf. habil. dr. Dana Lucia Stănculeanu, președinte S.N.O.M.R, este unul dintre cei mai vocali susținători ai proiectelor tinerilor din societate, de la prima ediție a Forumului, până la conștientiza-
și cu abordări inovatoare. De asemenea, nu putem subestima importanța unității între cei mai avansați în carieră și cei începători, unitate între generații. Rolul generației mele este de a călăuzi și de a ajuta cât mai mult posibil pregătirea generațiilor tinere. Cred că avem o datorie morală să ne bucurăm pentru orice șansă în plus pe care o putem oferi noilor generații, chiar dacă noi nu am putut beneficia de ea la începuturile carierei. Consider că în centrul tuturor eforturilor noastre trebuie să se afle pacientul, iar misiunea noastră comună este de a le oferi cea mai bună îngrijire posibilă”, este mesajul de susținere pe care conf. habil. dr. Dana Lucia Stănculeanu îl transmite de câte ori are ocazia.
40 www.revistamedicalmarket.ro Articole de specialitate Oncologie
Forumul Științific Național al Tinerilor Medici Oncologi, ediția a-III-a, 18-20 Mai 2023, Sibiu
Forumul Științific Național al Tinerilor Medici Oncologi, ediția a-III-a, 18-20 Mai 2023, Sibiu
• Fotolii pentru chimioterapie cu structură solidă, care asigură confortul pacienților pe toată durata tratamentului. • Acestea au o capacitate de până la 200 kg, asigurând stabilitate și siguranță. • În funcţie de model, înălţimea și toate segmentele sunt reglabile electric prin intermediul unui panou de comandă. • Modelele de vârf oferă și poziția Trendelenburg. Alte variante disponibile la cerere.
• În imagine sunt prezentate fotolii produse de către furnizorul nostru, CFS (Italia).
LĂMPI CHI RURGICALE
• Lămpile chirurgicale produse de către furnizorul ACEM (Italia), STAR LED 3 NX și STAR LED 5 NX au o configuraţie formată din 3, respectiv 5 reflectoare care produc un con de lumină omogenă, intensă și foarte ușor focusabilă cu ajutorul sistemului de ajustare automată a diametrului fasciculului de lumină. • Datorită designului compact, suplu și practic, lămpile sunt deosebit de ergonomice, ușor de poziţionat și compatibile cu aerul laminar din sala de operaţii • Proprietăţile igienice deosebite ale lămpilor se datorează formei și materialului foarte ușor de curăţat, precum și mânerului detașabil și sterilizabil • Funcţiile lămpii pot fi selectate cu ajutorul unui dispozitiv inovativ tactil – panoul de afișaj I-SENSE®: ușor de citit, ergonomic și ușor de curăţat • Sistemul de lămpi asigură o lumină omogenă și fără umbre datorită opticii speciale cu LED care direcţionează perfect fasciculul luminos în funcţie de necesităţi • Aria vizuală este perfect iluminată, asigurând confort vizual și condiţii de lucru excelente • Datorită funcţiei ENDO (lumină pentru endoscopie), aceste lămpi pot fi folosite cu succes și pentru intervenţii chirurgicale minim invazive • Sistemul este prevăzut cu cameră video localizată în centrul lămpii, în interiorul mânerului sau pe un braţ suplimentar.
MOBILIER MEDICAL





• Echipa Favero Health Projects (Italia) este cunoscută pentru profesionalismul și experienţa sa, în sectorul spitalicesc, acumulată pe parcursul anilor de muncă în contact cu clientul, identificând nevoile și transformându-le în idei și concepţii aplicate pe produse.

• Datorită vastei experienţe a companiei Favero în echiparea spitalelor, MEDICAL LOGISTIC MALL a adus în România un stil nou în organizarea departamentelor medicale.
• Favero poate dota astăzi spații complete caracterizate prin durabilitate, igienă, flexibilitate, confort, funcționalitate în utilizarea de zi cu zi, prin integrarea unei game variate de produse specifice.

Echipamente medicale și infrastructură Instrumentar și consumabile Consultanţă specializată
BUCUREȘTI Str. Giuseppe Garibaldi nr. 8-10 Sector 2, București Tel 031-4250226 Tel 031-4250227 office@medicalmall.ro IAȘI Aleea Al O. Teodoreanu nr 55A, Bloc 1, Demisol, Iași, Județul Iași Tel: 0725119393 Fax: 0372-560250 www medicalmall.ro TIMIȘOARA Str. Martir Cernăianu nr 18 Timișoara, județul Timiș Tel. 0356-110233; Fax 0372-560250 office@medicalmall.ro
FOTOLII CHIMIOTERAPIE
THYMUSKIN® FORTE,

Ce este THYMUSKIN®?
Thymuskin este sistemul dermatologic care combate căderea părului și activează o nouă creștere a părului atât pentru bărbați, cât și pentru femei. Oferă toleranță foarte bună pentru diferite tipuri de căderea părului și nu are efecte secundare chiar la utilizare indelungată. Eficacitatea dovedită clinic a fost confirmată de studii științifice independente Complexul activ patentat GKL-02
Actiunea Thymuskin se manifestă prin intermediul complexului patentat de peptide timice, GKL-02, complex care imită extractul natural de timus și nu conține ingrediente derivate de la animale.
În această bibliotecă de peptide, treizeci și trei de derivați de aminoacizi sunt combinați chimic într-o manieră statistică unul cu celălalt și combinați fizic cu șaptesprezece aminoacizi naturali, fie ca atare, fie ca sărurile lor și ca derivați ai acestora. Greutatea moleculară medie a peptidelor individuale este cuprinsă între 180 și 600 daltoni, facilitând astfel penetrarea prin stratul folicular al pielii după ce a fost aplicat pe scalp.
Ingredientul inovator patentat GKL02 este responsabil pentru revitalizarea și regenerarea părului, precum și pentru susținerea creșterii noilor fire de păr. Hidratarea și îngrijirea firului se realizează prin extracte naturale, așa cum sunt cofeina, vitamina E și urzica. Formula este completată de pantenol și proteine vegetale.
Cum acționează THYMUSKIN® FORTE?
Studiile preclinice au relevat efectul imunologic al THYMUSKIN asupra foliculilor piloși. Peptidele timice din Thymuskin acționează ca modulatori direcți ai creșterii foliculilor de păr. Studiul din 2012
a investigat acele peptide timice care sunt implicate în creșterea părului. Timulina, așa cum este conținută în Thymuskin®, a arătat o eficacitate terapeutică deosebit de ridicată. Studiile au observat o rată de creștere uimitor de ridicată în diferite mostre de foliculi de păr umani. Structura chimică a timulinei determină sistemul neuroendocrin să producă hormonii responsabili pentru creșterea naturală a părului, cum ar fi prolactina, tirotropina și altele.
1. Prelungește faza de crestere prin inhibare enzimatică (ex. 5-alpha-reductase)
2. Regenerează foliculii de păr prin activarea keratinocitelor

3. Stimulează creșterea prin intermediul diferitelor peptide timice
Thymuskin® oferă un sistem unic de îngrijire a părului în contextul combaterii căderii părului. THYMUSKIN® FORTE,
EFICIENȚĂ DOVEDITĂ
Citostaticele administrate în timpul chimioterapiei determină pierderea părului (cel mai adesea reversibilă) prin inhibarea creșterii celulare și a activității foliculilor piloși, iar evoluția depinde de medicamentele folosite, de doze și durata terapiei. În majoritatea cazurilor părul cade complet în 3-5 săptămâni de la prima ședință de chimioterapie. În mod normal părul crește la loc în aproximativ 3 luni după încheierea chimioterapiei, dar s-au semnalat tot mai multe cazuri de tulburări persistente de creștere a părului.
Studiile și cercetările științi fice observaționale controlate efectuate
în cadrul clinicilor de dermatologie și
clinicilor universitare din Germania și la nivel internațional au verificat eficacitatea Thymuskin asupra tuturor formelor de cădere a părului.
»» Thymuskin oferă de trei ori mai multe șanse de a preveni căderea părului sau a alopeciei totale reversibile sub terapie citostatică comparativ cu placebo1 sau grupul de control2
»» Cu o terapie citostatică „ușoară“, Thymuskin menține starea părului la până la 94% dintre pacienți2
»» Utilizarea Thymuskin poate să mențină starea părului semnificativ mai frecvent pentru pacienții care suferă de terapie citostatică „ușoară“ (5-fluorouracil) decât pentru pacienții care urmează terapie citostatică „agresivă“ (Adriamycin)3
»» Efectele pozitive ale Thymuskin asupra stării părului sunt mai semnificative pentru pacienții cu cancer mamar sau colon decât pentru pacienții cu cancer esofagian sau gastric3
Evoluția Alopecia medicamentosa prin aplicarea THYMUSKIN®
1. Pierdere completă a părului la o lună de la începerea chimioterapiei. Începe aplicarea Thymsukin la 6 săptămâni de la începerea chimioterapiei
2. Creștere semnificativă a părului la 4 săptămâni de la încheierea chimioterapiei
3. Creștere constantă și susținută la 2 luni de la încheierea chimioterapiei THYMUSKIN®, produs în Germania, este eficient de peste 30 de ani, devenind unul dintre liderii mondiali în tratamentul pentru căderea părului și regenerarea noilor fire de păr.
Referinte:
1. Lüpke N.-P.: Zusammenfassender Bericht zur adjuvanten lokalen Anwendung von Thymu-Skin-Präparationen bei Patienten unter zytostatischer Chemotherapie. Sonderdruck aus: Deutsche Zeitschrift für Onkologie 1/90
2. Denck H., Wallner M.: Abschlußbericht über den 2. Teil Wien der Thymuskin-Haarstudie. Ludwig Boltzmann Institut für klinische Onkologie im Krankenhaus der Stadt Wien-Lainz. 29.5.1989
3. Köhler C. O.: Unterschiedliche Erhaltung des Kopfhaares bei Chemotherapie mit verschiedenen Therapeutika. Interner Bericht aus dem Deutschen Krebsforschungszentrum, Heidelberg, Abteilung Medizinische und Biologische Informatik.
4. Maurer H. R.: Preclinical Investigation of Thymic Preparations GKL-01, GKL-02 Interner Untersuchungsbericht 2005
5. Journal of Investigative Dermatology, Online-Vorabpublikation, 8. März 2012; doi:10.1038/jid.2012.2
Pharmconnect Services
+40 720 110 363; office@pharmconnect.ro www.pharmconnect.ro • www.onconect.ro
42 www.revistamedicalmarket.ro Articole de specialitate Oncologie
îngrijire alături de tratamentul de bază în cazurile de alopecie indusă de medicamente citostatice
1. Prelungirea fazei de creștere prin protejarea împotriva DHT (dihidrotestosteronului) și a enzimelor
2. Activarea keratinocitelor (celulele care formează firul de păr) din matricea firului de păr
3. Stimularea creșterii de către diverse peptide timice
Produse de îngrijire a pielii în timpul terapiei, dedicate pentru piele sensibilă, alterată
Produse pentru îngrijirea pielii ulterioară terapiei
un concept unic și holistic de sprijin pentru pacienții cu cancer cu efecte secundare ale pielii




în cosmetică oncologică și produse de îngrijire a
pentru piele sensibilă,
desiderm® - Specialistul
pielii
alterată de tratamentele oncologice
PHARMCONNECT SERVICES +40 720 110 363, office@pharmconnect.ro • www.onconect.ro
Utilitatea IHC și ISH în diagnosticul oncologic de precizie
În prezent, cancerul ocupă locul secund pe podiumul bolilor cauzatoare de deces, fiind responsabil de decesul a 9,6 milioane la nivel global anual. Denumirea de cancer (neoplasm, tumoră malignă) cuprinde un număr mare de boli, care își au originea în acele celule care suferă modificări ce le permit eludarea mecanismelor stricte de control ale proliferării celulare și/sau care sunt capabile să „păcălească” sistemul imunitar al organismului. Consecința acestui dezechilibru este înmulțirea necontrolată a celulelor, cu depășirea limitelor obișnuite ale țesutului de origine și invadarea zonelor adiacente, precum și răspândirea lor la distanță, în alte organe. Procesul de răspândire a celulelor tumorale și dezvoltarea de noi mase tumorale maligne la distanță de tumora inițială se numește metastazare și reprezintă una dintre cauzele major de deces în cazul cancerului1. Toate acestea au ca fundament instabilitatea genetică, asigurându-se diversitatea genetică a tumorilor, cu consecințe imediate în selectarea liniilor celulare tumorale cu agresivitate înaltă și/sau refractare la chimioterapia antitumorală2
Irina Nuca, asistent universitar Dr., medic primar Genetica medicala *, Ștefania Brebu, biolog*,
Iuliu Cristian Ivanov biolog principal Dr.*, Roxana Popescu - șef lucrări Dr., medic primar Genetica medicala **,
Cosmin-Teodor Mihai, biolog principal Dr., CS II Dr.*, Eva Gavril - asistent universitar Dr., medic specialist Genetica medicala*
*Investigatii Medicale Praxis,
**UMF „Grigore T. Popa” din Iași
Modificările apărute la nivelul genomului celular tumoral pot fi identificate fie prin recunoașterea segmentelor de ADN/ARN modificate prin tehnica de hibridizare in situ (ISH), fie prin identificarea proteinelor (elemente fundamentale din structura celulelor și a țesuturilor) prin tehnici de imunohistochimie. Ambele tehnici au la baza conceptul de complementaritate, fie între două secvențe ADN, fie între anticorp și antigen 3
Hibridizarea in situ este utilă în localizarea secvențelor specifice ale acizilor nucleici la nivel de cromozomi sau de țesuturi, stabilind de exemplu structura cromozomului. Există mai multe variații ale aceste tehnici, țintite fiind fragmentele de ADN, ARN (ARN mesager, ARN necodantlung sau microARN) de la nivelul secțiunilor tisulare,
celulare sau din celule tumorale circulante. De asemenea, tehnica FISH (utilizează fluorocromi în vederea detectării) este utilizată în diagnosticul medical pentru a determina structura cromozomilor.
O altă tehnică utilizată în diagnosticul molecular de interes in diagnosticul oncologic este reprezentată de către imunohistochimie, tehnică asemănătoare celei ISH, dar în acest caz reacția nu mai are loc la nivel de acizi nucleici, ci de antigen (ce poate fi o proteină) și un anticorp dezvoltat să se lege specific doar la acel antigen. Detecția legăturii dintre antigen și anticorp, pentru a putea fi vizualizată, se bazează fie pe atașarea la anticorpul țintit a unui fluorocrom (compus chimic ce devine fluorescent în anumite condiții), a unei enzime capabile să transforme un compus dintr-o culoare în alta, fie prin utilizarea unui anticorp secundar care se va lega la anticorpul țintit către antigen. Acest anticorp secundar va purta de asemenea, unul dintre sistemele de detecție anterior descrise. Ulterior, existența antigenului de interes, localizarea lui în țesut, abundența acestuia vor putea fi apreciate prin examinarea lamei la microscop. Prezența antigenului va fi evidențiată prin apariția la nivelul lamei examinate a unor zone colorate (în general maronii) sau a semnalelor fluorescente. Aceste semnale vor apărea doar dacă anticorpii s-au legat specific de țintele lor, în caz contrar nu vom avea semnal. Astfel, crește nivelul de încredere al medicului anatomopatolog și ulterior a medicului oncolog în stabilirea unui diagnostic precis și în adoptarea unei conduite terapeutice adecvate.
Aparent, gestionarea bolii maligne și a metastazelor este dificil de realizat, dar descoperirea precoce și aplicarea unor tratamente eficiente cresc semnificativ șansele de supraviețuire, cu reducerea mortalității. Aceste deziderate pot fi atinse prin diagnosticul precoce a cancerelor simptomatice și prin aplicarea unor programe de screening la nivelul persoanelor care prezintă susceptibilitatea de a dezvolta această boală.
De cele mai multe ori diagnosticul de certitudine în ceea ce privește existența unui cancer este pus pe baza biopsiei prelevate de la pacient. Ulterior, aceasta este prelucrată pentru identificarea modificărilor caracteristice întâlnite în diferitele tipuri de cancere, obținându-se informații și în ceea ce privește gradul de diferențiere (cât de diferită este masa de celule canceroase față de celulele normale). Dar analizele clasice de histologie sunt limitate, deoarece nu pot discrimina între diferitele subtipuri celulare, dar mai ales moleculare. Progresul geneticii și biologiei moleculare a permis identificarea de ținte moleculare și de noi căi de intervenție terapeutică.
Astfel, la unii pacienți care prezintă cancer de sân sau cancer gastric, gena HER2 este amplificată (se găsește într-un număr mai mare comparativ cu celulel normale), urmare a transformării maligne și progresiei cancerului, această situație conducând la exprimarea într-un număr mai mare a proteinei HER2 la suprafața celulelor canceroase. Această amplificare a genei HER2 a fost asociată cu un prognostic nefavorabil, risc crescut de recurență și cu șanse mai reduse de
44 www.revistamedicalmarket.ro Articole de specialitate Oncologie

supraviețuire. De asemenea, unele studii au arătat că se poate stabili o relație între nivelul de expresie a HER2 și răspunsul la anumite scheme terapeutice. Estimarea nivelului de expresie a HER2 este important pentru inițierea tratamentului cu anticorpi monoclonali țintiți pentru proteina HER2. Studiile clinice au arătat că pacienți care prezintă o supraexprimare la nivelul celulelor tumorale a HER2 și/sau o amplificare a genei HER2 au un beneficiu mai mare de pe urma tratamentului cu anticorpii monoclonali. Ulterior, după marcarea țintelor moleculare aceste sunt vizualizate și interpretate de către specialistul anatomopatolog, rezultatul fiind înaintat către medicul oncolog ce va lua decizia terapeutică de urmat 4. Sau, în cazul detecției proteinei PD-L1 în probele de țesut prelevate de la pacienți cu cancer pulmonar (NSCLC) se bazează pe tehnica de IHC, permițând evaluarea oportunității de tratament cu anticorpi monoclonali. Astfel, pe baza rezultatelor de la IHC se determină procentul de celule ce prezintă o marcare parțială sau totală a membranei celulare cu anticorpii specifici. Ulterior, tratamentul țintit și personalizat va conduce la controlul mult mai precis a creșterii tumorale și la o prelungire a ratei de supraviețuire5.
Dar de la biopsia prelevată și până la un diagnostic, proba pacientului trece print-un proces complex, de durată și care nu exclude apariția unor artefacte. De aceea, automatizarea și găsirea unor soluții tehnice de standardizare a procesului de prelucrare și marcare oferă în prezent posibilitatea prelucrării unui număr crescut de probe, cu un grad de reproductibilitate crescut.
Din categoria automatelor de prelucrare a probelor histologice sub formă de preparate histologice este și Dako Omnis, sistem automatizat penttu ISH și IHC. Acesta automatizează complet fluxul de marcare / hibridizare, având protocoale standardizate, verificate și reproductibile. Kiturile dezvoltate pentru acest echipament oferă

posibilitatea unei marcări / hibridizării nesupravegheate de către utilizator, rezultatul fiind tot timpul același.
De exemplu, HercepTest™ mAb pharmDx dezovolat pentru Dako Omnis este unul dintre cele mai recente kituri pentru determinarea semicantitativă a supraexprimării proteinei HER2 în țesutul mamar inclus în parafină și prelucrat pentru histologie. Anticorpul primar utilizat este un anticorp monoclonal (clona DG44) licențiat și obținut printr-un proces patentat, atingând astfel o specificitate mult mai crescută comparativ cu alți anticorpi. Totdată, poate fi utilizat în fluxuri automate de colorare, fiind validat pe echipamente de colorare automate în echipamente automate de colorare (de exemplu Dako Omnis).
Când se vorbește de diagnostic de precizie în domeniul oncologiei moderne, trebuie să ținem cont că uneori strategia terapeutică este influențată și stabilită pe baza informațiilor furnizate de metodele de histologie și genetică moleculară, care au posibilitatea de a discrimina la nivel molecular diferențele între două sau mai multe subtipuri tumorale.
Astfel, extrem de importantă este performanța anticorpului primar și, în final, a întregului kit de a identifica corect și specific subtilele diferențe dintre subpopulații tumorale. Performanța kitului de diagnostic imunohistochimic de la Dako Omnis a fost evaluată prin comparație cu performanțele altor kituri similare de marcare pentru HER2. În acest scop, evaluarea comparativă a rezultatelor a folosit 119 de probe de cancer de sân preselectate, ce au acoperit întreaga plajă de niveluri de expresie (scor IHC 0, 1 + , 2 + , 3 +). Sensibilitatea și specificitatea kiturilor de diagnostic a fost determinată pe baza consensului IHC și pe baza determinării FISH, conform recomandărilor ASCO/CAP (2018).
În cazul tumorilor HER2 negativ (IHC 0, 1+, 2+ și FISH negativ) și HER2-pozitiv
(IHC 3+, 2+ și FISH pozitiv) ambele teste au indicat corect statusul tumoral. Kitul validat pe Dako Omnis a fost capabil să identifice 2 tumori care prezentau amplificări specifice ca având scorul 2 pe scala IHC, în timp ce kitul testat în parale le-a identificat ca fiind IHC 1+. Alte 4 cazuri au fost identificate ca fiind IHC 2+ de către HercepTest (mAb),cu un raport FISH <2 dar cu un unmăr crescut de copii, au fost identificate ca fiind negative de către kitul testat în paralel. Astfel, HercepTest (mAb) detectează cu o mai mare sensibilitate expresia HER2 în tumorile cu amplificare genică (grup ISH 1) și cu număr de copii crescut, precum și în cazul tumorilor cu nivel scăzut de expresie HER2 (HER2 IHC2 + /FISH negativ sau IHC 1 +) 8.
Datele au demonstrat că HercepTest (mAb) a prezentat atât specificitate ridicată (100%), cât și sensibilitate ridicată (100%), ceea ce ar putea fi critic în selecția pacienților pentru noile opțiuni de tratament care vizează HER2.
Cu toate că tehnicile de diagnostic și tratament au evoluat foarte mult, nu trebuie să uităm că este mai ușor să prevenim, decât să tratăm și în acest sens riscul de cancer poate fi redus prin: renunțatul la fumat; evitarea sau reducerea consumului de alcool; alimentație sănătoasă și menținerea unei greutăți corporale normale; vaccinarea împotriva HPV și hepatitei B; evitarea expunerii la radiații ultraviolete; minimizarea expunerii la radiații ionizante; limitarea expunerii la aerul poluat din exterior și interior.
Bibliografie
1. Cancer. www.who.int/health-topics/cancer.
2. Hanahan, D. & Weinberg, R. A. Hallmarks of Cancer: The Next Generation. Cell 144, 646–674 (2011).

3. Sjørup, A. H. Education Guide Immunohistochemical Staining Methods Sixth Edition.
4. Agilent Dako Omnis. HER2 IQFISH pharmDx, IFU. www. agilent.com/cs/library/brochures/29051_her2_iqfish_pharmdx_brochure_us_version.pdf.
5. Agilent Dako. PD-L1 IHC 22C3 pharmDx Interpretation Manual – NSCLC. www.agilent.com/cs/library/usermanuals/public/29158_pd-l1-ihc-22C3-pharmdx-nsclc-interpretation-manual.pdf.
6. Anistalista. Español: Hibridacion in situ con fluorescencia sobre el gen HER2 y el centromero del cromosoma 17. Celulas de un tumor de mama.English: HER2 FISH on Breast Cancer. (2017).
7. Nephron. PD-L1 lung ca. - high mag. https://commons. wikimedia.org/wiki/File:PD-L1_positive_lung_adenocarcinoma_--_high_mag.jpg#filelinks (2018).
8. Rüschoff, J. et al. Comparison of HercepTestTM mAb pharmDx (Dako Omnis, GE001) with Ventana PATHWAY anti-HER-2/neu (4B5) in breast cancer: correlation with HER2 amplification and HER2 low status. Virchows Arch. 481, 685–694 (2022).
46 www.revistamedicalmarket.ro Articole de specialitate Oncologie
Fig. 1 Imaginea obținută prin tehnica ISH a genei HER2 și a centromerului cromozomului 17 din celulele unei tumori mamare6 (foto stânga). Imaginea obținută prin tehnica IHC sugestivă pentru detecția PD-L1 într-un adenocarcinom pulmonar7 (foto dreapta) . Imagini preluate din Wikimedia Commons, CC BY 4.0

Îngrijirile paliative: o necunoscută în
Romania?
O analiză detailată a situației îngrijirii paliative în România a fost subiectul unui amplu reportaj publicat în 20 ianuarie 2022 într-o publicație medicală cu bună circulație în mediul sanitar. Din cele relatate de doamna Mălina Dumitrescu, administrator la un centru de îngrijiri paliative, rezultă că în România îngrijirea paliativă este înțeleasă parțial și anume se iau în considerare doar acele aspecte ale îngrijirii din ultimele zile sau săptămâni de viață.


prezent, se pune un accent prea mare pe internarea, instituționalizarea pacienților. Este nevoie de dezvoltarea resursei umane (pregătire, educație, supraspecializare, de formare continuă) dar și de finanțare, medicație, de politici care să stimuleze furnizorii de servicii de îngrijire paliativă.
și valoarea cantitativă a componentelor importante ale corpului, cum este masa musculară, cantitatea de grăsime, cantitatea de apă (intra și extracelulară), se inventariază starea nutrițională la acel moment al pacientului.
„Este un lucru pe care publicul ar trebui să-l înțeleagă: poți face multe lucruri pentru calitatea vieții pacientului și familiei, chiar și atunci când vindecarea nu e posibilă.“
Trebuie menționat că OMS (Organizația Mondială a Sănătății) consideră ÎNGRIJIREA PALIATIVĂ ca și UN DREPT al OMULUI și nerespectarea lui este considerată MALPRAXIS și VĂTĂMARE CORPORALĂ.
Paliația începe odată cu prezența recidivei tumorale sau cu apariția primei metastaze la distanță și nu este numai îngrijirea în ultima perioadă a vieții.
În ROMÂNIA nu se dă ATENȚIA cuvenită pacienților incurabili. Din datele prezentate reiese că în România 176.000 de persoane ar avea nevoie de acces la îngrijire paliativă în ultimul an de viață. Serviciile existente pot asigura doar 20% din necesar. În 13 județe din țară nu există niciun furnizor de îngrijire paliativă. Din intervenția domnului Conf. Dr. Vladimir Poroch (IRO Iași) au reieșit câteva soluții care ar putea schimba în bine peisajul îngrijirilor paliative în România. În
În general, este cunoscut că pacienții oncologici sunt subnutriți. Studiul efectuat de grupul condus de Nicole Erikson încă din anul 2018 a evidențiat că MALNUTRIȚIA este prezentă la peste 50% dintre pacienții oncologici (2018 în ERNAHRUNGSUMSCHAU). Starea de nutriție a pacientului are un rol esențial și determinant în tolerarea și acceptarea terapiei, în răspunsul la terapie și asupra calității vieții pacientului. La pacienții cu o stare nutriționala adecvată, efectele secundare rezultate din terapia aplicată sunt reduse iar recidivele tumorale sunt și ele mai rare.
Se impune stabilirea statusului nutrițional al fiecărui pacient oncologic chiar de la începutul luării în evidența oricărui serviciu oncologic prin efectuarea așa zisului Minimal Nutrition Assessment (MNA). Faptul că statusul nutrițional nu face parte integrantă din datele despre starea generală a pacientului la luarea în evidența oricărui serviciu oncologic și considerat în deciziile comisiilor oncologice, când se decide secvența terapeutică este o mare deficiență a sistemului, ce trebuie remediată.
Stabilirea statusului nutrițional se realizează cu ajutorul unei investigații denumite BIOIMPEDANTĂ (BIA) (Fig 1). Astfel, având valoarea BMI (Body Mass Index) stabilită din raportul între greutatea și înălțimea pacientului și având acum

palmelor aplicată pe cele 2 mânere și pielea tălpilor aplicată pe senzorii tălpilor permite stabilirea componentelor care intră în calculul stării nutriționale: masa musculară, grăsimea, cantitatea de apa intra și extracelulara precum și repartizarea în corpul pacientului.
Esențială pentru înțelegerea importanței efectuării acestei determinări la fiecare pacient oncologic este faptul că pierderea în greutate, care în majoritatea cazurilor de fapt a adus pacientul la medic și se manifestă cu luni de zile înainte de prezentarea la medic, este abia acum luată în serios.
48 www.revistamedicalmarket.ro Articole de specialitate Oncologie
Fig. 1. Aparat pentru măsurarea bioimpedantei (BIA). Înregistrarea potențialelor electrice între pielea
Prof. Univ. Dr. Chiricuță Ioan Cristian
Centrul de Radioterapie AMETHYST, Otopeni
Dr. Amadeo Grigorean
Tehnician Nutriționist, MEDICOVER București
Fig 2. Mecanismele ce guvernează toxicitatea mediată de chimioterapie la un pacient oncologic sarcopenic (1). Procesele inflamatorii prezente la orice pacient oncologic induc pierderea de masă musculară (2) și grăsoasă (3). Pacienții sarcopenici necesită reducerea dozei citostaticelor datorită toxicității mărite (4), întreruperea chiar a tratamentului (4) si au un prognostic în general mai rezervat. Costurile sunt crescute și efectele așteptate de la terapie nu sunt cele dorite. (Vega MC et al. Einstein. 2016; 14(4):580-4. Sarcopenia and chemotherapy – mediated toxicity)

Ce se ascunde de fapt în această informație?
Inițierea oricărei terapii la un pacient oncologic poate induce efecte secundare (inapetență, modificarea gustului și a mirosului). Dacă este prezentă și componenta psihică și mai sunt prezente și dureri produse de tumora primară sau de metastaze sau chiar de terapie (candidoză orală și esofagită) atunci este direct afectată nutriția pacientului și consecința este reducerea aportului nutrițional. Acesta este doar începutul, care mai mult, accelerează pierderea în greutate în continuare. În general, multiple procese inflamatorii sunt induse de prezența tumorii (efecte paraneoplazice) și ele contribuie la pierderea în greutate (Fig. 2). Pacientul oncologic reduce mult exercițiul fizic deci automat pierde masă muscular iar dacă mai este și în vârstă, această pierdere este mult grabită. La acest pacient, vârsta cronologică nu este susținută de starea reală de nutriție ci el are de fapt o „vârstă biologică” ce guvernează răspunsul la tratament și chiar supraviețuirea.
Factorii clinici, ca de exemplu efectele secundare ale terapiei, starea psihică a pacientului și durerea pot induce o reducere a statusului nutrițional. Împreună cu procesele inflamatorii manifeste la nivel subclinic, favorizate de prezența tumorii primare sau a metastazelor, au ca efect direct pierderea în
greutate a pacientului. Reducerea mobilității pacientului produsă de boală în sine și tratament au și ele ca și consecință inițierea pierderii masei musculare și slăbirea imunității pacientului. Orice proces inflamator induce și modificări metabolice ce favorizează reducerea mobilității dar și apariția de procese inflamatorii secundare. Pierderea masei musculare crează pacientului accentuarea fatigabilității, a asteniei și inducerea unei stari depresive care acum favorizeaza inducția casexiei. Cu cât acest proces nu este din timp recunoscut și diagnosticat și nu se inițiază așa zisele măsuri paliative (determinarea BIA, nutriție, îmbunătățirea mobilității, combaterea inflamațiilor), el alunecă într-o fază care poate fi chiar și ireversibilă și duce implicit la moartea prematură a pacientului.
Este bine cunoscut că la 10-20% dintre pacienții oncologici, cauza decesului nu este cancerul în sine ci casexia.
Pierderea în greutate și o stare nutrițională precară sunt direct legate de morbiditate și mortalitate. Prezența procesului tumoral în sine favorizează apariția citochinelor proinflamatorii și astfel procesul inflamator devine foarte repede sistemic.
Un centru de îngrijiri paliative, dacă nu are și posibilitatea de măsurare a BIOIMPEDANȚEI, nu ar trebui să aibă aprobare de funcționare iar la cele care sunt în situația aceasta ar trebui imediat acționat, pentru a putea efectua măsurători BIA asupra paci-
entului. Un “NUTRIȚIONIST” dintr-o clinică oncologică, dacă nu are acces la rezultatul măsurătorii BIA, prezența lui nu este sustenabilă ci este chiar inutilă și va face un deserviciu pacientului. Din păcate, aceasta este situația actuală în toate clinicile cu profil oncologic. Bine ar fi să existe și excepții. Cerințele sub formă de OBLIGATIVITATE ale unui centru de paliație:
Înființarea unei unități de stabilire a statusului nutrițional și determinare a Bioimpedanței (BIA) Efectuarea MNA - Minimal Nutrition Assessment
Recomandarea de către „nutriționist“ a remedierii stării de malnutriție înainte de începerea tratamentului oncologic.
Control lunar BIA.
Aplicarea unui PORT sau PEG pentru asigurarea aportului nutrițional, când este cazul.
Analiza corporală prin BIOIMPEDANȚĂ (BIA)
Analiza structurală corporală prin BIOIMPEDANȚĂ se realizează cu ajutorul unui dispozitiv (Fig. 1) ce permite determinarea componentelor constitutive ale corpului uman și anume: masa musculară, cât de dezvoltată este și unde este repartizată în corp, masa osoasă, masa grăsimii din corp și repartizarea ei, hidratarea și distribuția apei intracelulare și extarcelulare și prezența unor colecții lichidiene precum ascită, lichid pleural, edeme etc.
Ce înseamnă pentru “sănătate” această determinare a componentelor BIA ale corpului pacientului?
Vârsta “metabolică” este influențată în principal de procentul de grăsime și de starea de hidratare a organismului. Dacă se consideră și masa musculară, atunci vârsta ”metabolică” reprezintă un raport optimal al acestor 3 componente. Orice abatere de la optimal a uneia sau a mai multor componente duce la o modificare a vârstei “metabolice”, ce poate fi mai mare sau mică decât vârsta cronologică. La pacientul oncologic cu deficit nutrițional, cu pierderea grăsimii și reducerea masei musculare este greu de stabilit “o vârstă metabolic reală”, care să reflecte acel “potențial biologic” ce-l face apt pentru terapia stabilită (chimioterapie, imunoterapie, chirurgie, radioterapie etc). În chirurgia generală și în chirurgia transplantelor de organe, această investigare a statusului nutrițional este obligatorie și, fără această evaluare, pacientul nu este programat pentru operație. La pacienții cu deficit nutrițional se începe un program de
49 Articole de specialitate Oncologie 2023 - 2024
fără progresiunea bolii (PFS) la pacienții cu cancer pulmonar (non small cell) metastazat sub terapie cu inhibitorii de PD-1 (nivolumab sau pembrolizumab) în funcție de prezența sau nu a sarcopeniei. În cazul prezenței sarcopeniei, supraviețuirea fără progresia bolii (PFS) este mult mai redusa (curba marcată cu roșu). (Semnificație statistică p = 0,004) Shiroyama et al. Sci Rep 2019; 9: 2447)
nutriție ce are ca scop îmbunătățirea stării generale a pacientului, lucru care reduce diferite riscuri operatorii.
De ce în oncologie nu se face această evaluare a statusului nutrițional, similară cu aceea din chirurgie, unde este standard de ani de zile? Această procedură simplă ar crea posibilitatea selecționării acelor pacienți care chiar ar profita de terapia indicată.
La un pacient oncologic cu o pierdere în greutate de 5 kg dar fără rezerve de grăsime, vârsta lui “biologică” reală nu este cea indicată de aparat, care îl clasifică având o vârstă “metabolică” ce corespunde unei persoane cu o vârstă cronologică mai mică. În realitate, pacientul cu o pierdere accentuată în greutate, fără masă grăsoasă și masă musculară, care este mult sub normal intră în zona sarcopeniei, adică în ansamblu este aproape de apariția casexiei. Ce fel de terapie se mai poate oferi unui asemenea pacient dacă nu se începe un program bine definit de nutriție? Indicele sarcopenic ar putea fi
4. Supraviețuirea pacienților oncologici în funcție de starea nutrițională și de prezența sarcopeniei. (modificat după Prado et al (Lancet Oncol 2008; 9(7): 629-35))


musculare este indicele sarcopenic. Există mai multe metode de determinare a acestui indice. Cel mai frecvent utilizată la evaluarea pacientului chirurgical este aprecierea stării masei musculare a mușchiului psoas la nivelul celei de a 3-a vertebre lombare (Fig. 3).
Prado și colaboratorii au publicat în revista Lancet Oncol 2008; 9(7): 629-35 rezultatele unui studiu în care a fost semnalată dependența supraviețuirii pacienților oncologici (tumori gastro-intestinale și pulmonare) de starea lor de nutriție. Pacienții fără sarcopenie au supraviețuit mult mai mult decât pacienții cu sarcopenie (Fig. 4).
Apariția sarcopeniei este un proces insidios, care scapă ușor observației pacientului și a personalului medical sau a rudelor. Anorexia și lipsa activității fizice este cadrul ideal în care acest proces este accelerat.
Shiroyama și echipa (Sci Rep 2019; 9:2447) au investigat la pacienții cu cancer pulmonar (non small cell) efectul terapiei cu inhibitori PD-1. Impactul prezenței sarcopeniei asupra răspunsului la terapia cu nivolumab sau pembrolizumab a fost statistic semnificativ diferită (p=0,004).
Fig. 6. Supraviețuirea pacienților tratați cu radiochimioterapie pentru tumoră esofagiană recidivată în funcție de absența sarcopeniei (curba roșie) și prezenta sarcopeniei (curba albastră). (Ying-Ying Xu et al. Front Oncol 2021)

un parametru util în acest fel de evaluare, în chirurgie este deja un standard.
În niciun protocol terapeutic nu este luată în considerare starea nutrițională în cadrul comisiei oncologice în care se decide atitudinea terapeutică pentru un pacient. Cât va profita un asemenea pacient de o imunoterapie când imunitatea lui este deja grav afectată de procesele inflamatorii secundare deja prezente și a stării de nutriție deficitară?
În limba greacă cuvantul “casexie” înseamnă „stare proasta”. Casexia este determinată și de inflamație și apetit redus. Aceasta reprezintă o problemă serioasă pentru pacienții cu cancer. Această stare, dacă mai este asociată și cu activitatea fizică redusă, crează o situație cu o toleranță mai redusă la orice tratament oncologic.
Cum influențează starea de nutriție răspunsul la terapie?
Un parametru nou ce apreciază starea de nutriție și în special pierderea masei
Prevalența sarcopeniei a fost asociată cu un răspuns redus la terapie. În figura de mai jos (Fig. 5) este reprezentată supraviețuirea fără progresiune a bolii (PFS) la pacienții tratați cu inhibitori PD-1 (nivolumab sau pembrolizumab) în funcție de lipsa sarcopeniei sau în prezența sarcopeniei.

Efectul prezenței sarcopeniei la 184 de pacienți cu cancer esofagian recidivat și tratați prin radiochimioterapie postoperativă a fost examinată de echipa YingYing Xu (Fig. 6). (Ying-Ying Xu et al. Front Oncol, 11, 2021).
Întrebări la care trebuie găsit un răspuns:
Ce dezavantaje are un pacient oncologic la care nu se efectuează o evaluare a stării sale de nutriție la luarea în evidentă oncologică?
La pacienții oncologici, stabilirea indicelui de prezență a sarcopeniei trebuie să fie obligatorie.
Este motivată aplicarea terapiei standard conform protocoalelor actuale unui pacient la care indicele sarcopenic este ridicat?
O mulțime de cheltuieli ar putea fi economisite, resursele ar putea fi folosite rațional iar speranțele ar crește.
50 www.revistamedicalmarket.ro Articole de specialitate Oncologie
Fig. 3. Stabilirea indicelui sarcopenic prin aprecierea masei musculare a mușchiului psoas (contur rosu) la nivelul celei de a 3-a vertebre lombare.
Fig. 5. Supraviețuirea
Fig.
Un progres în prevenirea și tratamentul radiodermitelor
Sân1 - Înainte de radioterapie, pacienta a primit 4 cicluri de Adriamicină și ciclofosfamidă + 12 cicluri de chimioterapie cu paclitaxel
Cap şi gât2 - Tratamentul în timpul chimioterapiei și radioterapiei concomitente
Indicat de la doza inițială de radiații pe durata radioterapiei până la recuperarea completă a pielii
Un gel nesteroidian pentru gestionarea pielii uscate și a erupțiilor cutanate
Leziuni cutanate legate de adezivii medicali (MARSI)3
Începerea tratamentului cu
Plăci eritematoase cu cruste și ulcerații4
Începerea tratamentului cu
Fabricat de: Stratpharma AG, Aeschenvorstadt 57, CH-4051 Basel, Elveția
Indicat pentru utilizarea pe toate tipurile de răni, piele toxică și compromisă, inclusiv:
• Dermatită asociată incontinenței










• Piele pruriginoasă și xerotică
• Reacții cutanate
• Leziuni cutanate legate de adezivii medicali (MARSI)
• Reacție la perfuzie
• Sindromul mână-picior
ro.strataxrt.com ro.stratactx.com

Distribuit în România: Meditrina Pharmaceuticals S.R.L., Intrarea Măguricea Nouă, nr. 7-7A, Sector 1, București, România, tel: +4 021 211 71 83

Referinţe: 1. Date la dosar, 2015 (Hospital Universitario de Fuenlabrada, Hospital Ruber Internacional. Madrid, Spania. Stratpharma AG.
2. Villandiego, IA. (2018). Journal of Cancer Therapy, 9, pp. 1048-1056. 3. Shergold, J., Poster prezentat la reuniunea științifică anuală a Grupului de hematologie/oncologie pentru copii din Australia și Noua Zeelandă (ANZCHOG), iunie 15-17, 2017, Adelaide, Australia. 4. Cubiró Raventós X. et al. (2018). SKINmed, 17, pp. 298-304.

StrataXRT, StrataCTX sunt dispozitive medicale de clasa IIa, cu marcaj CE pentru Europa, înregistrate TGA și FDA.


Stratpharma Romania stratpharma_romania
 7 zile după radioterapie. Începerea tratamentului cu StrataXRT
După 72h de tratament cu StrataXRT După 10 zile de tratament cu StrataXRT
Sesiunea 17 de radioterapie.
Începerea tratamentului cu StrataXRT
Sesiunea 26 de radioterapie.
După 14 zile de tratament cu StrataXRT
7 zile după radioterapie. Începerea tratamentului cu StrataXRT
După 72h de tratament cu StrataXRT După 10 zile de tratament cu StrataXRT
Sesiunea 17 de radioterapie.
Începerea tratamentului cu StrataXRT
Sesiunea 26 de radioterapie.
După 14 zile de tratament cu StrataXRT
SX-CT-RO-051-1-0923
Sesiunea 30 de radioterapie. După 21 zile de tratament cu StrataXRT
După 5 zile de tratament cu StrataCTX
StrataCTX
După 14 zile de tratament cu StrataCTX
StrataCTX
Genetica
în cancerul de prostată
schimbări de paradigmă în medicina de precizie a secolului XXI
Genetics in prostate cancer - paradigm shifts in precision medicine of the 21st century
Diagnosticul și tratamentul cancerului de prostată au cunoscut schimbări substanțiale în ultimele decenii. După demonstrarea hormonosensibilității cancerului de prostată de către Huggins și Hodges, introducerea dozării antigenului prostatic specific (PSA), terapia hormonală de deprivare androgenică, dezvoltarea și îmbunătățirea tehnicilor de prostatectomie radicală (deschisă, laparoscopică, robotică), metodele moderne de imagistică (scintigrafia, rezonanța magnetică nucleară, tomografia cu emisie de pozitroni), biopsia prostatică ecoghidată, fusion și RMN ghidată precum și medicația adresată cancerelor prostatice hormonorezistente și/sau metastatice au contribuit în mod semnificativ la îmbunătățirea impresionantă a diagnosticului și rezultatelor tratamentului pacienților cu cancer de prostată, anticipând transformarea cancerului de prostată dintr-o boală incurabilă într-o boală cronică, cu care se poate trăi o lungă perioadă de timp.
Privind însă datele studiilor publicate în ultimii ani, putem constata că, odată depășită euforia pionieratului cu evoluții aparent spectaculoase, rezultatele consistente obținute în diagnosticul și tratamentul cancerului de prostată au fost însoțite și de abordări care s-au dovedit a fi suboptimale:
• au fost incluși frecvent în programe de screening pacienți la care acest lucru nu era necesar
• a fost subestimat screeningul la persoanele mai tinere și aparent sănătoase
• au fost supratratate cazuri low-risk
și subtratate cancere high-risk iar valoarea prag a PSA de 4 mg/ml nu a
reprezentat niciodată o limită care să confere siguranță diagnostică ci, cel mult, o bornă de orientare Stratificarea cancerelor de prostată în grupe de risc (nomogramele Partin, MSKCC, Briganti, CAPRA, NCCN) se face în funcție de PSA, stadiul tumoral, examenul histopatologic, volumul tumoral și densitatea PSA, având ca rezultat un procent de aproximativ 30% de cazuri la care se face upstaging/ downstaging-ul, respectiv upgrading/ downgrading-ul, conform unui studiu recent publicat în European Urology. Cu toate acestea, mortalitatea prin cancer de prostată a scăzut cu peste 50% față de etapa pre-PSA iar medicina secolului XXI, orientată spre terapii personalizate, face pași importanți bazându-se pe progresele deja înregistrate, eliminând abordările greșite/ suboptimale și integrând elementele moderne de diagnostic și tratament.
Odată cu încheierea proiectului de secvențiere a genomului uman (19902003, cu ultimele 8% din genele ADN

secvențiate în 2022), evaluarea genetică a cancerelor, în general, și a cancerului de prostată în particular a cunoscut o dezvoltare consistentă. Astfel, dacă înainte de 2016, ghidurile NCCN (National Comprehensive Cancer Network) menționau în capitolul dedicat cancerului ovarian și a celui de sân că gena BRCA ar putea fi implicată în cancerul de prostată ereditar, din 2016 se recomanda screeningul precoce al pacienților cu istoric familial de cancere BRCA 1/2 pozitive iar din 2018 ghidurile NCCN pentru cancerul de prostată iau în considerare testarea genetică a liniei germinale pentru mutațiile BRCA la persoanele cu risc (istoric familial, vârstă tânără la debut, cancer metastatic). Din 2022 această testare are valoare de recomandare la cazurile cu risc.
Se consideră că 20-30% dintre cancere au o componentă genetică. Astfel, sunt definite în prezent
• cancerele prostatice ereditare (1015% din totalul cancerelor), la care
52 www.revistamedicalmarket.ro Articole de specialitate Oncologie
Prof. Univ. Dr. Alin Cumpănaș
Clinica de Urologie, UMF Victor Babeș, Timișoara



Viva Combo Generator cu radiofrecvenţă pentru ablaţie Soluţie minim invazivă pentru patologia oncologică hepatică, biliară şi pancreatică Str. Nisipari, nr. 27, sector 1, București; tel/fax 021.317.91.88/89, e-mail: office@vavian.ro
mutația/mutațiile genetice ereditare sunt dovedite (genele BRCA, HOXB13, sindromul Lynch etc)
• cancerele familiale (15-20%) – fără mutații genetice (încă) identificate dar cu agregare familială clară , la care patogeneza poate să implice factori genetici/epigenetici și condițiile de viață
• cancerele sporadice (70-80%) – fără componentă ereditară
Anamneza pacienților cu cancer de prostată ar trebui să includă în mod obligatoriu şi evaluarea de risc familial pentru boală cu determinism genetic: vom întreba asupra rudelor de grad unu, de ambele sexe precum şi asupra rudelor de gradul doi (bunici, unchi, mătuşi, veri pe linie maternă şi paternă), ne vom interesa de istoricul familial de cancer de prostată şi de sân, ovar, endometru, pancreas, colon, gastrointestinal şi leucemie. De asemenea, este importantă în anamneza familială vârsta de apariție a cancerelor în familie precum şi vârsta eventualelor decese prin cancer. În plus, este important de evaluat prin anamneză dacă a fost vorba de cancere agrsive sau nonagresive, metastatice sau nonmetastatice, cu sau fără chimioterapie.
Testele genetice actuale utilizate în cancerul de prostată se împart în două mari categorii: testele liniei germinale (pentru mutațiile genetice moștenite de la genitori) și testele genetice somatice (din celulele tumorale). Majoritatea genelor liniei germinale testate sunt gene de recunoaștere și reparație a leziunilor ADN rezultate în faza de replicare (BRCA, ATM, MSH, HOXB13 etc.)
În funcție de grupa de risc, Ghidurile NCCN din 2023 recomandă testarea genetică a liniei germinale
(cel puțin pentru mutații ale BRCA) la pacienții low-risk cu istoric familial încărcat sau la cei cu cancer intraductal sau cribriform precum și la toți pacienții cu risc intermediar sau crescut (17% dintre aceștia s-au dovedit a avea una sau mai multe mutații genetice cu risc, cel mai frecvent mutațiile BRCA). Mutațiile BRCA se asociază cu un risc de 2-6 ori mai mare de a dezvolta cancer de prostată, cu un risc de 8-9 ori de a dezvolta cancer de prostată sub 65 ani comparativ cu pacienții cu non-mutații, risc mai mare de cancer agresiv (Gleason 8+, N+, metastaze). Există studii care au arătat că în cazul pacienților cu cancer de prostată în program de supraveghere activă, riscul de upgrading este de 42% la purtătorii de mutații BRCA față de 23% la ne-purtători. Prin urmare, se poate aștepta ca pe viitor testarea genetică a liniei germinale (statusul de ne-purtător de mutații) să reprezinte un criteriu de includere în supravegherea activă.
Testarea genetică somatică (din materialul tumoral) evaluează peste 300 de gene, TMB (tumor mutation burden) sau MSI (microsattelite instability) precum și DNA liber circulant (cfDNA).
În prezent, dincolo de evaluarea riscului potențial de a dezvolta cancer de prostată/forme agresive ale acestuia, există deja implicații terapeutice:
• mutațiile genelor de recunoaștere și reparare a leziunilor ADN (ATM, BRCA 1, BRCA 2) sunt favorabile tratamentului cu inhibitori PARP (olaparib) sau chimioterapiei cu produși pe bază de platină
• genele de mismatch repair (MSH 2, MSH6, MLH1, PMS2) creează premisele unui răspuns favorabil la imunoterapia cu checkpoint inhibitors
Evaluarea mutațiilor genetice este una laborioasă, care beneficiază de programe complexe informatice și de computere dedicate performate, fiind necesare analize a zeci de mii de secvențe de baze, repetate de mai multe ori pentru e evita erorileTestarea genetică prin metoda NGS – next generation sequencing este obligatorie pentru a obține rezultate de calitate, în contrast cu testele ieftine care pot oferi rezultate incomplete sau eronate. Este important ca pacienții să fie informați asupra acestor aspecte și să aleagă să efectueze teste genetice de calitate, chiar dacă aceasta implică costuri semnificativ mai mari.
În concluzie, progresele recente în genetică și implicațiile acestora în cancerul de prostată vor trebui:
• să ne facă mai atenți la evaluarea istoricului familial al pacienților cu cancer de prostată, pentru a identifica pacienții la care vom recomanda testarea genetică (linia germinală sau somatică) în funcție de istoricul familial și histologia tumorii
• să ne permită să definim mai bine grupele de risc și alegerea tratamentului corespunzător
• să alegem, în echipa multidisciplinară (împreună cu oncologul, radioterapeutul, anatomopatologul, radioimagistul și geneticianul) tratamentul adecvat – un pas spre medicina de precizie și medicina personalizată
• nu în ultimul rând, consider că este rolul nostru, al urologilor, ca așa cum am popularizat și am reușit să implementăm dozarea PSA, să informăm pacienții, medicii de familie și colegii din alte specialități despre importanța evaluării factorilor de risc genetic și a importanței acestuia în succesul tratamentului cancerului de prostată.
54 www.revistamedicalmarket.ro
Oncologie
Articole de specialitate


Wolf-e Robotics S.R.L. Jud. Prahova, România +40 733 263 259 offic e@w olf e.r o www.wolfe.ro DEZINFECȚIE cu lumină UVC Roboți mobili și autonomi | Dispozitive smart Servicii Abonament "DAaaS" | Platformă integrată Consultanță proiectare | Sesiuni Demo CoBOT-Ultra WolfBOT CoBOT-Lite AER Breez Beam Lift AER 500+ Wolf-SENSE AER S WolfBOT-Mini AER & SUPRAFEȚE
PowerPICC-catheter (BARD)
PowerPICC-catheter (BARD)


• Termen de
• Termen de
implantare
implantare
până în 6 luni
până în 6 luni
• Cu sau fără heparină
• Cu sau fără heparină
• Substanță de contrast 5ml/s
• Substanță de contrast 5ml/s
• Loc.de acces v.cefalică X
• Loc.de acces v.cefalică X
Tratament post-radioterapie
Tratament post-radioterapie
PRO ERA
PRO ERA
Lipogel Relipidizant
Lipogel Relipidizant

• Stimuleaza hidratarea, restaurand stratul hidrolipidic al pielii si asigurand protectie.
• Stimuleaza hidratarea, restaurand stratul hidrolipidic al pielii si asigurand protectie
• Asigura reducerea pierderii trans-epidermica a apei.
• Asigura reducerea pierderii trans-epidermica a apei.
• Potrivit pentru pielea sensibila (sugari, copii, varstnici) si pentru pielea rosie si iritata
• Potrivit pentru pielea sensibila (sugari, copii, varstnici) si pentru pielea rosie si iritata
• Actioneaza ca un “booster”, oferind hidratare si protectie de lunga durata.
• Actioneaza ca un “booster”, oferind hidratare si protectie de lunga durata.
E-mail: moraru.mirela@ramido.ro www.ramido.ro • ww w .me d i c alma g azi n r o
Tel: 0744 649 289 E-mail: moraru.mirela@ramido.ro www.ramido.ro • ww w .me d i c alma g azi n . r o
RAMIDO STAFF
BARD® MISSION® Pistol semiautomat UF biopsie tisulară

BARD® MARQUEE® Pistol dublă funcție: automat și semiautomat UF biopsie tisulară

BARD® MAGNUM® Pistol automat reutilizabil biopsie tisulară

ENCOR ENSPIRE® Sistem de biopsie reutilizabil cu vacuum
BARD® MONOPTY® Pistol automat UF biopsie tisulară
Designed and sized for visibility
The breast tissue marker ’s distinctive twirled ring shape and profile aids in its visibility


Polymer and gel free
The Nitinol ring design limits the materials introduced into your patient’s breast because it is not embedded in collagen, polymer or gel
Self-incorporating design
As the Breast Tissue Marker is deployed, it self-incorporates directly into tissue assisting in accurate placement


Rig id, easy-to-use applicator design
e applicator features a 17g needle with a beveled tip ion of markers during deployment in ultrasound pendently or through a coaxial



Breast Tissue Marker
Soluția completă în biopsie Tel.: 0740.640.941; 0729.856.025, Fax: 031.434.40.93 office@ramido.ro , www.ramido.ro, www.medicalmagazin.ro R AMID O STAFF
Oncodermatologie – prezent și viitor în tratament
Abstract: It is generaly accepted that stem cells are at the origin of cancers, including cutaneous ones. Every different types of cells of the skin and mucous membranes could generate a cancer; in practice, the most frecvent ones are basocellular carcinomas and squamous cell carcinomas are reunited under the name „non-melanomatous skin cancers“ (NMSC) and the most aggressive cancers represented by malignant melanomas represent the second group (MM). For both categories the diagnostic is based on clinical signs, dermoscopic examinations and anatomopathological aspects. Early types of NMSC are treated by cryocauterisation, electrodessication or laser distruction. More difficult cases have the main indication surgical excision with control of possibles metastases in local lymphatic nodes. Alternatively the radiotherapy is effective in both. If patients can not support or refuse surgery or radiotherapy, topical applications of cytostatics (5-fluoro-uracil) or, better, immunomodulators (imiquimod) are indicated. For NMSC with metastases biological therapies sometimes associated with chemotherapy are available now: vismodegib and sonidegib (CBC), pembrolizumab and cisplatinum/ docetaxel (CSC). For MM, even the most precocious cases have the surgery fallow by corporal medical imaging (CT, PETCT, RMN) as the main indication. In metastatic cases biological new therapies are useful: Vemurafenib for BRAF + cases, Pembrolizumab, Nivolumab, Ipilimumab, Bevacizumab. Personalised ARN vaccines against surface antigenes of melanoblastes are a great hope for future.
UMF. „Iuliu Hațieganu” Cluj, Dept. Dermatologie

Tegumentul împreună cu mucoasele corespunzătoare este cel mai greu organ al corpului, având 16 kg în medie, și unul din cele mai extinse în suprafață, totalizând circa 1,9 m pătrați. Acest lucru înseamnă că posedă un mare număr de celule stem, activate în cazul diverselor injurii cutaneo-mucoase, în scop fiziologic reparator. Aceleași celule stem stau, după majoritatea teoriilor actuale, și la originea diverselor neoplazii cutaneo-mucoase, prin inițierea de diviziuni celulare necontrolate, sub acțiunea factorilor oncogeni externi sau/și interni. Tegumentul este totodată și un organ expus direct la acțiunea factorilor oncogeni de mediu, însuși rolul său fundamental fiind acela de interfață (o barieră interactivă) între mediul intern al organismului și mediul exterior. Tegumentul implică o
structură complexă, cu numeroase populații celulare diverse care conlucrează pentru asigurarea diverselor funcții vitale, barieră, protecție actinică, chimică, biologică, sensibilitate, homeostazie termică și altele. Oricare din aceste populații celulare poate genera o neoplazie specifică: keratinocite, melanocite, fibroblaști, mastocite, celule endoteliale, limfocite, receptori nervoși cum sunt celulele Merkel, macrofage - dar cu frecvențe foarte diferite. Cancerele cutaneo-mucoase de tip fibrosarcoame, angioendotelioame, cu celule Merkel sau mastocite sunt rare, în timp ce cancerele provenind din celule stem keratinocitare sau melanocitare sunt extrem de frecvente. Din motive practice de tratament al celor mai frecvente neoplazii cutanate, acestea au fost clasificate în mare în două categorii: carcinoame cutanate non-melanomatoase (CCNM) și respectiv carcinoame cutanate melanomatoase (MM).
În prima categorie intră carcinoamele bazocelulare (CBC) și carcinoamele spinocelulare (CSC) ca fiind de departe cele mai frecvente (și cu principii terape-
utice bine codificate), precum și rarități: carcinomul cu celule Merkel (multiplu recidivant, intens metastazant, intratabil deocamdată), neurinoame maligne, mastocitoame maligne și altele, toate la ora actuală fără vreun tratament eficace și bine codificat.
Categoria melanoamelor maligne este a doua ca frecvență, sunt neoplazii cu proceduri de tratament bine codificate și eficace.
Două grupuri aparte sunt formate de neoplaziile cu punct de plecare în limfocitele permanent rezidente în ganglionii limfatici cutaneo-mucoși, care formează grupul limfocitoamelor cutanate și respectiv neoplaziile cu punct de plecare în macrofagele locale, care formează grupul histiocitozelor X, ambele rare și dificil de tratat.
Carcinoamele bazocelulare derivă cel mai probabil din celulele-stem foliculare situate în zona bulge a sacului folicular. În esență aceste carcinoame sunt un fel de foliculogeneză aberantă, motiv pentru care nu apar niciodată pe mucoase; cresc foarte lent și, fapt important, metastazează extrem de rar, deoarece produc intrinsec o pseudomembrană bazală care
58 www.revistamedicalmarket.ro Articole de specialitate Oncologie
Prof. Univ. Dr. Alexandru Tătaru
împiedică contactul cu rețeaua limfatică sau/și vasculară locală. Ca atare, perioada de intervenție utilă se întinde de-a lungul mai multor ani de la debut.
Carcinoamele spinocelulare derivă din celulele-stem epidermice, adesea prin evoluția unor leziuni preneoplazice cum sunt keratozele actinice, apar și pe mucoase, unde uneori sunt implicate virusurile HPV oncogene, cresc mai rapid, perioada de intervenție utilă se restrânge la 6 – 12 luni, iau contact direct cu rețeaua limfatică locală și metastazează în circa 15 -20% din cazuri în ganglionii limfatici loco-regionali și rar, sub 5% din cazuri, în diverse organe interne pe cale sanguină. O localizare frecventă este pe buza inferioară deoarece aceasta primește direct radiația ultravioletă solară.
Se descriu rar și carcinoame mixte bazo și spinocelulare, cu evoluția mai agresivă tipică unui CSC.
Diagnosticul se bazează pe semnele clinice, dermoscopia vascularizației tumorale și examenul histologic al biopsiei/piesei de excizie.
Tratamentul formelor incipiente implică diverse metode de distrucție sau înlăturare a tumorii suspecte: se poate chiureta (metodă acceptată doar în SUA), criocauteriza/diatermocauteriza electric sau prin radiofrecvență, vaporiza prin laser. Indicația de elecție este eliminarea chirurgicală cu controlul anatomopatologic al marginilor și explorări imagistice pentru eventuale metastaze. Deoarece rata de recidivă în cazul CBC este de peste 10% la 5 ani, indiferent de metodele de mai sus, este preferabilă excizia chirurgicală după metoda Mohs, cu controlul intraoperator al marginilor și profunzimii masei tumorale pe secțiuni multiple, efectuate orizontal și nu vertical.
Alternativa pentru pacienții la care nu se poate practica chirurgia sau o refuză este radioterapia de contact, cu doze totalizând 6 – 12 Grey, ambele cancere fiind deosebit de radiosensibile.
O situație deosebită apare în cazul pacienților cu numeroase keratoze actinice și eventual mai multe focare de transformare malignă în CSC, practic vorbim despre un câmp de cancerizare care trebuie eliminat; analog, alți pacienți pot prezenta concomitent multiple tumori maligne cutanate (atât CSC cât și CBC) pe fondul unor genodermatoze predispozante – mai ales sindromul ne-
vilor bazocelulari și respectiv xeroderma pigmentosum. În aceste situații se preferă distrucția tumorilor și a câmpului de cancerizare prin terapie fotodinamică (pentru a evita dozele mari de iradiere care ar fi necesare): acidul aminolevulinic, ca precursor porfirinic, este aplicat pe piele, devine intrakeratinocitar porfirină fotodinamică și se iluminează aria cu lumină roșie sau albastră pentru activare.
Tratamente morbistatice pot fi utilizate la pacienți care refuză orice intervenție sau comorbiditățile prezente nu permit altceva: aplicare de Imiquimod cremă pentru stimularea reactivității sistemului imun local. La limită se pot încerca și citostatice local, de exemplu 5-fluoro-uracil.
Metastazările beneficiază pe lângă intervențiile chirurgicale de terapii biologice țintite. Pentru CBC metastazat s-au dovedit parțial eficace terapiile de blocare a căii hedgehog cu vismodegib, respectiv sonidegib și de blocare a punctului de control al morții celulare programate cu cemiplimab și nivolumab. Pentru CSC metastazat au funcționat cu succes parțial inhibiția factorului de creștere epidermică prin cetuximab, respectiv dintre inhibitorii punctului de control este util pembrolizumabul.Dintre citostaticele clasice s-au dovedit parțial utile combinațiile carboplatin cu paclitaxel pentru CBC, respectiv cisplatin plus docetaxel pentru CSC.
Melanomul malign cutaneo-mucos derivă probabil din melanocite stem epidermice, de vreme ce 70% din cazuri apar pe tegument în prealabil indemn și doar 30% pe nevi melanocitari pre-existenți. Melanoblastele au încă din perioada de embriogeneză capacitatea de a a migra activ, astfel încât tumora melanocitară intră precoce și activ în contact practic concomitent cu rețeaua limfatică și cea vasculară subiacente, metastazarea fiind frecventă și rapidă.
Terapeutic excizia chirurgicală cu margine de siguranță inițială de 5 mm a tumorii suspecte este obligatorie, indiferent de starea clinică a bolnavului sau de opțiunile sale, dacă se are în vedere supraviețuirea la 5 ani. Examenul anatomopatologic este standardul de aur pentru diagnostic (uneori extrem de dificil, necesitând colorații imunohistochimice speciale) și oferă indicele Breslow (= grosimea tumorii) în funcție de care se stabilește toată conduita terapeutică ulterioară,
respectiv necesitatea investigațiilor imagistice detaliate ale ganglionilor limfatici peritumorali (scintigrafie), a celor locoregionali (ecografie de orientare urmată de scintigrafii) și a întregului corp (preferabil PET-CT) pentru identificarea eventualelor metastaze actuale, cu repetarea anuală a scanării corporale pentru evidențierea metastazelor apărute ulterior.
Caracterele embrionare recâștigate explică și relativa radiorezistență cât și răspunsul slab la citostatice în cazul melanoamelor. Mai active s-au dovedit tratamentele de imunostimulare nespecifică, actual rămâne validă administrarea de interferon – gama, cu oarecare efecte benefice inconstante.
Speranțele terapeutice actuale se îndreaptă către terapiile biologice cu efect țintit. Enumerăm pe scurt cele uzuale și de perspectivă imediată:
a. Inhibiția exprimării genei BRAF V600, modificată în circa 50% din MM – Vemurafenib;
b. Inhibitori ai punctului de control pentru moartea celulară programată – Ipilimumab, Nivolumab, Pembrolizumab;
c. Blocanți ai creșterii celulare – Bevacizumab;
d. În studiu la Johns Hopkins Hospital terapia pre-operatorie cu asocierea Nivolumab cu Relatlimab (anti-LAG 3);
e. Producerea de vaccinuri personalizate antitumorale – Moderna produce în 8 săptămâni un vaccin ARN personal, pentru circa 34 de antigene tumorale, obținute din piesa de excizie a pacientului, cu rezultate satisfăcătoare în reducerea ratei de recidivă.
Profilaxia primară pentru toate carcinoamele cutanate este un succes odată cu acceptarea largă de către populație a obiceiului de protecție solară și estimăm o altă îmbunătățire dacă și vaccinul anti-HPV va fi folosit pe larg. Există o speranță pentru vaccinuri probabil ARN antitumorale de protecție.
Profilaxia secundară rezidă actualmente în rețeaua dermatologică care oferă examinări dermoscopice de calitate, identificând riscul tumoral cu ani înainte de validare, cu posibilitatea de a folosi programe de inteligență artificială aplicate la aparatura ce examinează automat toată suprafața corpului (total body maping), ușurând enorm munca zilnică a dermatologilor.
59 Articole de specialitate Oncologie 2023 - 2024
O noua generatie in diagnosticul viscoelastic al HEMOSTAZEI
Principiul de masurare
• Thrombelastografie (miscare elastica)




• In timpul masurarii cupa de proba este rotita cu ajutorul unui element elastic iar pinul este stationar
• Unghiul de rotatie este masurat prin intermediul unui sistem de detectie capacitiv
• Corelatie excelenta stabilita prin intermediul tehnnolgiei Cupa - Pin
Analizorul ClotPro®
• 6 canale independente pentru a maximiza flexibilitatea
și accesibilitatea la alegere intre urmatoarele teste:
EX-test [prezentare rapida a procesului de coagulare]
FIB-test [nivelul functional al fibrinogenului]
IN-test [evaluarea heparinei, sensibila la F-VIII]
HI-test [IN-test cu inhibarea heparinei]
AP-test [inhibarea fibrinolizei cu aprotinina]
RRW-test (sensibilitate ridicata pentru anticoagulanti orali directi (DOAC) - de exemplu: rivaroxaban, edoxaban etc.)
ECA-test [Sensibilitate ridicata pentru antagonistii directi ai trombinei - de exemplu: dabigatran, argatroban]
TPA-test [evaluarea coagularii cu activarea firbrinolizei]
NA-test [non activated test]
• Incalzire rapida, directa, in infrarosu, a pozitiei de testare
• Analizor usor cu design compact



• Sistem usor de utlizat

Tehnologie tip „varf activ“
• Varful de pipeta contine un burete impregnat cu reactivii necesari liofilizati care se dizolva la transferarea probei de sange, astfel fiind eliminata manipularea acestora
• Gama de meniu de testare cuprinzatoare
• Stocarea reactivilor la temperatura camerei
• Pipetare electronica simpla, monovolum (volum unic340µL)


Interfata utilizator
! Display mare, touch-screen, full HD
! Afisaj pe un singur ecran care prezinta rezultatul obtinut, parametrii si curba grafica
! Cititor coduri de bare, gestionare utilizatori
! Pipetare ghidata electronic

! Optiuni de transmitere rezultate :
- conectivitate LIS / HIS
- vizualizare la distanta (remote)
- transmitere rezultate prin e-mail
C lo tP ro
Global Hemostasis
Citrated: K, KH, RT, FF (07-601)
Trombelastograful computerizat TEG® 6s este destinat analizării elasticității cheagului de sânge prin măsurarea proprietăților mecanice de la de inițierea formării până la lizarea acestuia fiind sensibil la toate interacțiunile dintre componentele celulare și plasmatice (factori de coagulare și fibrinoliză).
TEST DESCRIERE PROBĂ
Kaolin TEG1
Kaolin TEG with Heparinase2
RapidTEG3
Analiză cu activarea căii intrinseci. Această trasare generată de trombină identifică caracteristicile hemostatice subiacente și riscul de sângerare sau tromboză.
Elimină efectul heparinei în proba de testare. Utilizat împreună cu Kaolin standard TEG, evaluează prezența heparinei sistemice sau a heparinoidelor.
Analiză cu activarea atât a căii intrinseci cât și a celei extrinseci care accelerează procesul de coagulare în vederea obținerii cât mai rapide a proprietăților și caracteristicilor de coagulare.

Sânge integral citrat
TEG Functional Fibrinogen4
PlateletMapping®
Mapare plachetara ADP (07-615)
TEG PlateletMapping5

Un test activat pe cale extrinsecă care utilizează un inhibitor puternic de GPIIb/IIIa plachetar pentru a restricționa funcția plachetară în vederea izolării contribuției fibrinei în coagulare. Utilizat împreună cu Kaolin TEG se poate evalua contribuția relativă a trombocitelor și a fibrinei la tăria globală a cheagurilor.
Include o urmărire specifică a receptorului de trombină și a receptorului trombocitar (ADP/AA). Identifică nivelul inhibării și agregării plachetare, utilizând Kaolin TEG (care reprezintă potențialul hemostatic de bază al pacientului) ca și control.
Sânge integral heparinat
Departamentele pentru care utilizarea TEG® 6s aduce un plus calității actului medical și o scădere a costurilor asociate sunt: Urgențe, ATI, Chirurgie cardio-vasculară, Ortopedie, Neurologie, Oncologie, Transplant, Obstetrică-Ginecologie, Transfuzii, Neonatologie și Pediatrie.

1 Test cantitativ in-vitro care se folosește la monitorizarea pacienților ce prezintă tulburări ale coagulării.
2 Idem 1 pentru pacienți heparinizați.
3 Se folosește când este necesară determinarea rapidă (5 – 10minute) a tăriei cheagului de sânge (intervenții chirurgicale, tratamente cu anticoagulante heparinice, diferențierea între coagulopatie și sângerare mecanică).
4 Se folosește pentru a determina și identifica coagulopatiile asociate fibrinogenului (nivelul de fibrinogen, eliminarea ambiguităților asociate tăriei maxime a cheagului, anormalitate genetică legată de fibrinogen, diagnosticare CID).
5 Se folosește când este necesară monitorizarea strictă a nivelului de inhibare al funcției plachetare de către anticoagulante față de hemostaza de bază a pacientului, pentru identificarea potențialilor factori generatori ai sângerărilor, pentru ierarhizarea factorilor de risc în evenimentele trombotice, pentru determinarea eficacității terapiei antiplachetare precum și a rezistenț ei trombocitelor la terapie.
www.balmed.ro | office@balmed.ro | +40-213 275 269
Angiosarcomul hepatic – prezentare de caz
Angiosarcomul hepatic primar (AHP) este o tumoră malignă hepatică primară rară, cu origine în țesutul mezenchimal, fiind caracterizat printr-o vascularizație bogată. Prevalența în rândul tuturor tumorilor maligne hepatice primare este estimată la doar 0.1-2%. AHP se dezvoltă mai frecvent la pacienții cu vârsta de peste 60 de ani. Prezentarea clinică a AHP poate varia considerabil, de la absența simptomelor până la semne de insuficiență hepatică. În majoritatea cazurilor, simptomatologia este nespecifică la momentul diagnosticului inițial, iar în ceea ce privește aspectul imagistic este dificil de diferențiat de alte tumori maligne hepatice, fapt ce conduce la un diagnostic tardiv și la un tratament întârziat.
As. Univ. Dr. Ana Maria Ghiuchici
Clinica de Gastroenterologie și Hepatologie, UMF „Victor Babeș“ din Timișoara
Conf. Univ. Dr. Mirela Danilă
Clinica de Gastroenterologie
și Hepatologie, Universitatea de Medicină și Farmacie „Victor Babeș“ din Timișoara
Conf. Univ. Dr. Maria Cornianu
Clinica de Anatomie patologică, Universitatea de Medicină și Farmacie
„Victor Babeș“ din Timișoara
Dr. Nicoleta Iacob
Neuromed - Centru de diagnostic Imagistic, Timișoara
Prof. Univ. Dr. Ioan Sporea
Clinica de Gastroenterologie
și Hepatologie, Universitatea de Medicină și Farmacie „Victor Babeș“ din Timișoara
Prezentare caz clinic
Pacient în vârstă de 41 de ani, se prezintă în Ambulatorul de Gastroenterologie acuzând sindrom febril intermitent și dureri abdominale difuze. Nu prezintă antecedente personale patologice semnificative, iar istoricul familial este negativ. Nu este sub nici un tratament medicamentos, neagă consumul de toxice și nu se cunoaște alergic la nici o substanță. Se efectuează o ecografie abdominală la care se decelează: în lobul hepatic drept (LHD)
formațiune hipoecogenă, neomogenă, bine delimitată de aprox. 6/7 cm; altă formațiune în lobul hepatic stâng (LHS), subcapsular, cu componentă transonică de aprox. 5/6 cm și multiple formațiuni transonice/hipoecogene de aprox. 1-2 cm diseminate în LHS. Splenomegalie 15 cm cu o formațiune hiperecogenă de aprox. 6.5 cm. Fără lichid perihepatic sau în Douglas. Se decide internarea pacientului în Clinica de Gastroenterologie și Hepatologie pentru investigații și tratament de specialitate. Testele de laborator evidențiază leucocitoză ușoară, markeri virusali HBV/HCV - negativi, markeri tumorali – negativi. Examinarea ecografică cu substanță de contrast (CEUS) a formațiunilor hepatice este concludentă pentru metastaze hipovasculare unele cu zonă de necroză extinsă. Comportamentul la CEUS al formațiunii splenice este sugestiv pentru diagnosticul de metastază splenică. S-a efectuat CT cu SDC la care aspectul formațiunilor a fost sugestiv pentru diagnosticul de abcese hepatice și splenice sau determinări secundare hepatice și splenice necrozate. În evoluție, aspectul leziunii din LHS s-a modificat ecografic, cu creșterea în dimensiuni și apariția lichidului de ascită perihepatic. S-a efectuat puncție aspirativă la nivelul formațiunii din LHS cu aspirarea a 20 ml lichid sanguinolent. Având în verede evoluția nefavorabilă sub tratament conservator (pacient septic cu suspiciune de ruptură tumorală) se decide transferul pacientului în Clinica de Chirurgie în vederea intervenției chirurgicale.
Se intervine chirurgical pe cale laparoscopică și se constată un hematom organi-
zat perihepatic la nivelul LHS în contact cu fața anterioară gastrică și o formațiune tumorală hepatică în segmentul III-IV hemoragică de aproxiamtiv 7/5 cm diametru. Se evacuează hematomul perihepatic și se practică rezecție atipică hepatică pentru tumora hemoragică din segmentul III-IV. Se excizează piesa de rezecție prin minilaparotomie în flancul stâng. Intraoperator s-au facut următoarele observații: multiple leziuni hepatice diseminate în ambii lobi cu aspect de hemangioame și o formațiune la nivelul LHD segment VIII de aproximativ 8/6 cm în diametru cu aspect macroscopic de hemangiom; splina cu o formațiune macroscopic chistică localizată la polul superior de aproximativ 6/4 cm în diametru.
Raportul histopatologic şi imunohistochimic al tumorii rezecate a fost concludent pentru diagnosticul de angiosarcom hepatic de grad înalt cu creştere multinodulară şi pattern solid şi sinusoidal/vascular cu zone largi confluente de necroză tumorală şi hemoragică şi focare extinse de necroză supurativă.
Diagnosticul pozitiv a fost de angiosarcom hepatic de grad înalt complicat cu metastaze hepatice și splenice multiple.
Evoluție și prognostic
Însămânțarea pe medii de cultură a lichidului de puncție a evidențiat infecție
62 www.revistamedicalmarket.ro Articole de specialitate Oncologie
cu Acinetobacter baumannii. S-a inițiat terapia cu Colistin 1 mi U 3X3 mi U/zi + Meropenem 1 f 3X1 f/zi 10 zile conform antibiogramei, ulterior pacientul fiind referat către Clinica de Oncologie pentru tratament de specialitate. Evoluția a fost nefavorabilă cu exitus la 2 luni după operație.
Discuții
Angiosarcomul hepatic primar este o tumoră primară malignă de origine me-
zenchimală care afectează mai frecvent la pacienții vârstnici, simptomele în general sunt nespecifice. Diagnosticul este tardiv în majoritatea cazurilor, cu prognostic rezervat și supraviețuire medie fără tratament estimată la 6 luni.
Printre complicațiile frecvente sunt menționate ruptura spontană cu hemoragie intraperioneală, necroze tumorale și supurative, cu metastazare precoce la distanță (splină, os, plămân). Aspectul în imagistica cu contrast este atipic, diagnosticul diferențial cu hemangioendote-

liomul epiteloid, metastazele hepatice sau abcesele hepatice este dificil. Tratamentul standard rămâne rezecția chirurgicală. Transplantul hepatic nu este indicat datorită ratei crescute de recurență și supraviețuire scăzută posttransplant.
Concluzii
Angiosarcomul hepatic este tumorămalignă vasculară hepatică rară,agresivă cuopțiuni terapeutice limitate.
Diagnosticul este dificil și necesită confirmare prin examen histopatologic.
Particularitățile cazului sunt date de aspectul clinic al pacientului pe durata spravegherii în clinica noastră – pacient septic (angiosarcom complicat cu multiple microabcese) și diversele diagnostice vehiculate în imagistica superioarăabcese/hemangioame/ formațiuni chistice/ metastaze necrozate.
Bibliografie:
1. Averbukh LD, Mavilia MG, Einstein MM. Hepatic Angiosarcoma: A Challenging Diagnosis. Cureus. 2018 Sep 11;10(9):e3283.

2. Chien CY, Hwang CC, Yeh CN, et al. Liver angiosarcoma, a rare liver malignancy, presented with intraabdominal bleeding due to rupture--a case report. World J Surg Oncol. 2012;10:23.


3. Rujeerapaiboon N, Wetwittayakhlang P. Primary Hepatic Angiosarcoma: A Rare Liver MalignancyVarying Manifestations but Grave Prognosis. Case Rep Gastroenterol. 2020;14(1):137-149.


4. Sturm EC, Marasco IS, Katz SC. Multidisciplinary Management of Angiosarcoma - A Review. J Surg Res. 2021;257:213-220. doi:10.1016/j.jss.2020.07.026

63 Articole de specialitate Oncologie 2023 - 2024
Fig. 1 Formațiune hipoecogenă, neomogenă, bine delimitată de aprox. 6/7 cm în LHD
Fig. 3 Examinare CEUS. Comportamentul formațiunii de 2.3 cm din LHD în cele trei faze vasculare (A - faza arterială, B - faza portală, C- faza tardivă). Aspectul este sugestiv pentru metastază hepatică
Fig. 2 Formațiune în LHS, subcapsular, cu componentă transonică de aprox. 5/6 cm
Fig. 4 CT abdominal cu SDC - plan axial care evidențiază multiple formațiuni tumorale hepatice și splenice cu structura neomogenă ce prezintă priză de contrast heterogenă periferică în timp arterial.
Fig. 5 Angiosarcom hepatic. Colorație HE 40
Fig. 7 Angiosarcom hepatic. Imunohistochimie – celule endoteliale maligne CD 31+
Fig. 6 Angiosarcom hepatic. Imunohistochimie – celule endoteliale maligne CD 34+
Studiul clinic de 10 ani subliniază siguranța
şi eficacitatea implanturilor Eurosilicone®


GC Aesthetics, prin mărcile sale de top Eurosilicone şi Nagor, se dedică de peste 40 de ani să promoveze atât ştiința, cât şi siguranța produselor de estetică medicală din întreaga lume şi să livreze produse de cea mai înaltă calitate care să satisfacă nevoile clienților noştri şi ai pacienților lor.
Ca parte a angajamentului companiei de a furniza date de siguranță clinică pe termen lung pe dispozitivele sale medicale, GC Aesthetics a inițiat un studiu post-marketing de 10 ani care a implicat peste 500 de femei din 17 centre din Franța.
Cel mai mare studiu european publicat
Studiul a analizat implanturile mamare GC Aesthetics Eurosilicone, umplute cu gel atunci când sunt utilizate în augmentarea sânilor şi în chirurgia reconstructivă. Participanții la studiu au primit implanturi mamare texturate „Eurosilicone” pentru operații primare (423 femei) şi secundare (103 femei). Complicațiile au fost înregistrate la 3 luni şi anual, timp de 10 ani.
Datele celui mai mare studiu european publicat realizat până în prezent cu privire la implanturile mamare, intitulat „Date de siguranță de zece ani pentru implanturile mamare rotunde şi anatomice cu gel de silicon Eurosilicone”, au fost publicate în aprilie 2019 în „Aesthetic Surgery Journal Open Forum”.
„Rezultatele acestui studiu pe termen lung sunt printre cele mai bune din industrie”, a spus profesorul Franck Duteille, MD, chirurgie plastică reconstructivă şi estetică la Spitalul Universitar din Nantes şi investigator principal al studiului. Obiectivele au fost atinse şi pot fi observate prin ratele scăzute de complicații pentru contractura şi ruptura capsulară, precum şi prin numărul scăzut de pacienți care au prezentat complicații locale, cum ar fi hematom, serom şi infecție.
Carlos Reis Pinto, director executiv al GC Aesthetics, a adăugat: „Fiind o companie mondială de vârf cu peste 40 de ani de experiență şi dedicată asistenței medicale estetice a femeilor, suntem mândri de rezultatul acestui studiu clinic european la scară largă asupra implanturilor noastre mamare Eurosilicone. Acesta demonstrează şi ne întăreşte angajamentul de a furniza în mod continuu soluții sigure şi inovatoare clienților noştri şi pacienților lor.”

Constatări cheie*
Ruptură: 4,9%
Ratele de rupturi au fost scăzute şi semnificativ mai mici decât rezultatele obținute de implanturile concurente (9,3% şi 9%).
Contractură capsulară: 13,8%
Ratele contracturii capsulare (Baker Grade III şi IV) au fost scăzute şi comparabile cu rezultatele obținute de implanturile concurente (18,9% şi 12%).
Reintervenție: 13,3%
Ratele de reintervenție au fost scăzute şi semnificativ mai mici decât rezultatele obținute de implanturile concurente (18.6).
Concluzii
Rezultatele acestui studiu de 10 ani demonstrează siguranța şi eficacitatea implanturilor mamare rotunde şi anatomice cu silicon GC Aesthetics Eurosilicone®. Ratele de reintervenție, ruptură şi contractură capsulară au fost scăzute şi semnificativ mai mici sau comparabile cu implanturile concurente.
* Conform estimărilor de risc Kaplan-Meier pe 10 ani pentru pacienții din cohorta de augmentare primară. O estimare a supraviețuirii Kaplan-Meier măsoară probabilitatea statistică a apariției unei complicații într-o anumită cohortă de pacienți la un anumit moment în timpul unui studiu clinic.
Cea mai scazută rată de BIA-ALCL din lume.
Disponibile şi netexurate.
DISTRIBUITOR EXCLUSIV PENTRU ROMÂNIA ȘI MOLDOVA
Mobil: 0736.627.525 • 0731.361.550, E-mail: office@italtrade.ro, www.italtrade.ro

Adresa: Calea Bucureşti Nr. 74, Tunari, Ilfov, 077180

Suplimentele orale nutriționale – un subiect neînțeles
Sunt dr. Irina Mateieș, medic primar medicină de familie și nutriționist și din 2014 mă ocup de nutriția pacienților oncologici. Cu toate că malnutriția și pierderea masei musculare sunt probleme frecvente ale pacientului oncologic, acestea sunt, de multe ori, ignorate.
Pacientul cu cancer poate avea dificultăți în a-și atinge necesarul caloric și proteic dintr-o multitudine de motive – volumul de alimente pe care îl poate mânca se reduce, apar dificultăți de masticație și deglutiție, apare xerostomia, disgeuzia, stomatita/ mucozita, etc.
Pentru a putea învinge aceste obstacole, pacientul are nevoie de o formă de alimentație ușor de mestecat și înghițit dar care, în același timp, să nu aibă un volum foarte mare și, totuși, să-i acopere nevoile nutriționale.
O recenzie publicată în 2022 în revista Nutrition - cu titlul Dietary choices after a cancer diagnosis* (1) ne arată că alegerile pacientului oncologic, din păcate, nu sunt în concordanță cu nevoile sale. Adesea pacienții aleg recomandările utile în prevenție, pentru persoanele sănătoase, în loc de recomandările din ghidurile de nutriție oncologică. Recenzia evidențiază acest lucru cu ajutorul a două scheme simple, pe care le puteți vedea mai jos.
încât să le poată mânca cu ușurință și cum să aleagă alimentele care îi pot oferi, cu un volum mai mic, aportul caloric și proteic mai mare. Dacă acest prim pas nu este suficient, pasul următor ar trebui să fie adăugarea de suplimente orale nutritionale (găsite și cu denumirea de alimente dietetice speciale). Acestea sunt produse concentrate, complete din punct de vedere nutritiv, cu un aport crescut de calorii și proteine, pe lângă restul nutrienților necesari. Ele se pot găsi sub formă lichidă, gata preparate sau sub formă de pudră. De asemenea, acestea au diferite gusturi, existând chiar și variante cu gust neutru.
Suplimentele orale nutriționale reprezintă un ajutor excelent pentru combaterea deficitelor din alimentația pacienților oncologici. Ce am putut observa, în cei aproape nouă ani de lucru în domeniu, este că pacienții la risc de malnutriție care le folosesc reușesc, mai ușor, să prevină pierderea de kilograme și de masă musculară. Recomandarea utilizării suplimentelor orale nutriționale apare în toate ghidurile de nutriție pentru pacientul oncologic de la ESPEN (European Society for Enteral and Parenteral Nutrition)*(2) la ASPEN (American Society for Enteral and Parenteral Nutrition).
Am 2 exemple, din experiența personală, care îmi vin rapid în minte. Un exemplu este al unui pacient cu resurse economice limitate. Acest pacient era venit din alt oraș, singur, pentru a efectua tratamentul cu radioterapie la nivelul capului și gâtului. Pentru că tratamentul se efectua în condiții de ambulator, pacientul trebuia să se hrănească singur. Pe final de tratament nu se mai putea alimenta decât cu lichide. Fiind singur, fără acces la bucătărie și cu resurse financiare limitate, a început să slăbească. Întâmplarea a făcut ca acest pacient să primească, prin donație, mai multe flacoane de suplimente orale nutriționale hipercalorice, hiperproteice. Acestea fiind ușor de folosit, fără să necesite să fie gătite, au ajutat pacientul să ajungă la final de tratament cu un procent de scădere ponderală care nu a depășit 5%.
Deci pacienții ajung să aleagă alimente cu volum mare și greu de mestecat, cu aport caloric și proteic mic, ceea ce accentuează riscul de malnutriție și pierdere de masă musculară. Prin urmare pentru a contracara lipsa de informare corectă și avalanșa de informații incorecte din zona de social media, pacientul are nevoie în primul rând de consiliere nutrițională. Și în România, clinicile și spitalele au început să realizeze utilitatea consilierii nutriționale, dar accesibilitatea acestui serviciu este încă destul de dificilă în țara noastră.
În consultație pacientul află cum poate să modifice consistența alimentelor astfel
Pacientul trebuie să înțeleagă că dorința de a mânca „natural“, în contextul în care, de fapt, nu reușește să se alimenteze corespunzător, nu-l ajută. De asemenea, pentru a depăși frica de a nu consuma prea mult, este de ajutor să primească o recomandare clară, legată de cantitatea necesară și frecvența folosirii. Educarea pacientului legat de necesitatea existenței în dieta zilnică atât a proteinelor cât și a carbohidraților este foarte importantă. De asemenea, pacientul trebuie să înțeleagă că supradozarea cu anumite vitamine poate să reprezinte o problemă, dar că acest lucru nu se poate întâmpla cu suplimente orale nutriționale, atâta timp cât ele sunt folosite conform recomandărilor.
Complianța pacientului este ceea ce aduce succesul utilizării suplimentelor orale hipercalorice. Prin urmare, pentru a obține complianța este esențial să înțelegem care este bariera specifică care împiedică pacientul din a le folosi.
Un alt exemplu este al unui pacient după gastrectomie totală, care urma să efectueze tratamentul sistemic. Acest pacient era la el în oraș, avea și susținerea familiei și totuși imediat postoperator nu reușea să își atingă necesarul caloric și proteic, astfel încât să nu ajungă malnutrit în perioada de tratament sistemic. Prin adăugarea de suplimente orale nutriționale hipercalorice, hiperproteice în rețetele pe care le folosea zilnic, a reușit să își crească aportul și astfel să ajungă mult mai aproape de necesarul său zilnic de calorii, proteine și micronutrienți și să evite accentuarea malnutriției pe perioada tratamentului.
Dorința mea este ca toți profesioniștii din domeniul sănătății, care interacționează cu pacientul oncologic, să conștientizeze că aceste temeri există și să contribuie la combaterea lor și astfel să reușim, în echipă, să ajutăm pacientul să lupte împotriva malnutriției și sarcopeniei.
Dr. Irina Mateieș
Bibliografie
1. K.L. Ford et al. Dietary choices after a cancer diagnosis: A narrative review. Nutrition 103-104 (2022) 111838.


2. ESPEN guidelines on nutrition in cancer patients.Clinical Nutrition 36 (2017) 11-48.
3. E. Liljeberg et al.‘Between foods and medicines’: A qualitative interview study of patient experiences of the meaning and usage of oral nutritional supplements. Appetite 178 (2022) 106163.
66 www.revistamedicalmarket.ro Articole de specialitate Oncologie
Fig. 4. Common dietary changes among patients with cancer after diagnosis.

Caz rar de gastrită cu CMV imitând carcinomul gastric– prezentare de caz
Rare case of gastritis with CMV mimicking gastric carcinoma - case presentation
Patologia gastro-intestinală de etiologie infecţioasă nu prezintă caractere de specificitate și poate fi deseori neglijată. Vă prezentăm un caz al unei paciente de 61 ani, cu status biologic și imunitar precar, cu gastrită cu CMV și leziuni gastrice de neoplazie glandulară.
As. Univ. Dr. Constantin Budin1, As. Univ. Dr. Daniel Stăniloaie1, Dr. Andreea Tănase1, Dr. Alexandru Ilco1, Dr. Tarek Ammar1, Dr. Andrei Seceleanu1, Dr. Raluca Petre2, Dr. Anca Lăzăroiu3, Dr. Diana Cîşleanu4, Dr. Diana Iacob5,
1 – Clinica Chirurgie Generală
şi de Urgenţă 1, Spitalul Universitar de Urgenţă, Bucureşti
2 – Secţia de Anestezie şi Terapie Intensivă, Spitalul Universitar de Urgenţă, Bucureşti
3 – Departamentul de Anatomie Patologică, Spitalul Universitar de Urgenţă, Bucureşti
4 – Secţia Hematologie, Spitalul Universitar de Urgenţă, Bucureşti
5 – Boli Infecţioase, Spitalul Universitar de Urgenţă, Bucureşti
Prezentare de caz:
Pacienta în vârstă de 61 ani, de sex feminin, prezentată în multiple rânduri la Camera de Gardă pentru inapetenţă, durere abdominală în cadranul abdominal superior stâng, intoleranţă digestivă (vărsături post-prandiale) și scădere ponderală involuntară importantă (aproximativ 15 kg în 3 săptămâni).
Din istoricul personal reţinem: hepatită autoimună tratată cu Prednison, HTA în tratament, gangrenă gazoasă coapsă stângă operată în urmă cu 6 ani, TVP la nivelul membrului inferior stâng rezistentă la tratamentul anticoagulant oral, ITU recurente.
La prezentare – pacientă cu stare generală alterată, conștientă, cooperantă, OTS; tegumente și mucoase palide, intens deshidratate; cașexie; fără adenomegalii
superficiale decelabile la examenul clinic; torace fără particularităţi; abdomen cu panicul adipos slab reprezentat, pliu cutanat persistent, nedureros spontan, sensibil la palpare în hipocondrul stâng, fără semne de iritaţie peritoneală; ficat cu marginea anterioară la 3 cm sub rebordul costal drept; polul inferior al splinei palpabil sub jumătatea distanţei dintre rebord și creasta iliacă stângă, consistenţă fermă, sensibilă la palpare; tranzit intestinal prezent, încetinit.
EDS pune în evidenţă stomac cu mucoasă edemaţiată, cartonată, cu multiple ulceraţii în diferite stadii evolutive, de dimensiuni variabile, greu distensibil, cu pliuri gastrice șterse și ridică suspiciunea de linită gastrică. Se prelevează multiple fragmente bioptice. Rezultatul histopatologic descrie mucoasa gastrică cu multiple microabcese, ulceraţii parţial acoperite de detritus celular necrotic si exudat fibrino-leucocitar în contextul căruia se observă colonii polimicrobiene (inclusiv Helicobacter Pylori) – aspect sugestiv pentru o gastrită erozivă Helicobacter Pylori pozitivă, dar care nu poate exclude în totalitate un proces neoplazic.
Imagistic se pune în evidenţă stomac îngroșat mai ales la nivelul regiunii antro-pilorice, cu aspect edemaţiat; hepato-splenomegalie (splină cu ax bipolar de 18 cm).
Având în vedere rezultatul histo-patologic se decide administrarea de IPP în doze mari, tratament sub care pacienta nu își recapătă toleranţa digestivă.
Se repetă EDS cu biopsii multiple, aspectul endoscopic nefiind modificat semnificativ faţă de investigaţia precedentă. Examenul HP pune în videnţă aspect de ADK gastric moderat diferenţiat, su-
prainfectat acut, cu zone de ţesut de granulaţie.
Cu dignosticul de ADK gastric se pune indicaţia de gastrectomie totală radical. Se intervine chirurgical și se constată – stomac de dimensiuni relativ normale, seroasă de aspect normal, perete îngroșat, fără determinări secundare macroscopice intraperitoneale sau la nivelul organelor parenchimatoase, fără lichid de ascită; splină de mari dimensiuni, în tensiune, cu vasele splenice mult dilatate.
Se practică splenectomia în hil și gastrectomia totală radicală cu eso-jejunoanastomoză mecanică T-L pe ansă exclusă în Y a la Roux.
Evoluţie post-operatorie favorabilă în primele zile, marcată de alterarea stării generale și neurologică în ziua a 5-a post-operator. Pacienta devine dispneică, cu acidoză metabolică importantă, cu necesar de suport ventilator.
Se decide reinvestigarea prin CT toraco-abdomino-pelvin si se constată pneumoperitoneu în cantitate medie, dispus perihepatic si abdominopelvin anterior; revărsat pleural stâng ce asociază minima colabare pasivă a parenchimului adiacent.
Se decide relaparotomia, moment în care se pune în evidenţă dehiscenţa totală de anastomoză eso-jejunală, cu retragerea capătului esofagian endotoracic. Prin toracotomie dreaptă se reface anastomoza eso-jejunală T-T manual, cu fire separate.
Post-operator pacienta ramâne cu stare generală gravă, cu necesar de suport ventilator și vasopresor, oligurică, cu elemente de insuficienţă hepatică și renală.
Rezultatul HP al piesei de gastrectomie ridică suspiciunea de gastrită cronică activă, ulcerativă, difuză în contextual
68 www.revistamedicalmarket.ro Articole de specialitate Oncologie
Next-generation sequencing and microarray methods for liquid biopsy in cancer research





Maximize insights into a tumor’s biology from a simple blood draw using Illumina next-generation sequencing (NGS)


solutions for meaningful insights





of patients with advanced cancers do not have accessible tissue for biopsy ~20% more actionable alterations are identified in metastatic non-small cell lung cancer (mNSCLC) when liquid biopsy is added to tissue analysis ~15% Liquid biopsy analysis of CTCs elucidates tumor heterogeneity and cancer biology. Library prep Sequencing Multiple commercial offerings Multiple commercial offerings Multiple commercial offerings for genome, transcriptome, and epigenome NovaSeq X System NovaSeq 6000 System NextSeq 1000 or NextSeq 2000 System Multiple methods Open-source: Seurat, Monocle, chromVAR, etc Commercial: DRAGEN Single-Cell RNA pipeline, 10x CellRanger, Tapestri Insight, etc
Early detection and intervention are therefore critical for successful treatment, improved prognosis, and reduction of cancer mortality.
rare disease will go unseen. office@elta90mr.ro +4 021 232 26 94 www.elta90mr.ro
Example workflows for genetic disease research: No
infecţiei cu CMV și extinderea procesului inflamator la nivelul esofagului și duodenului, asociind elemente de vasculită și formare de microabcese, neoplazie intraepitelială glandulară gastrică focală de grad înalt și scăzut, Infecţia cu CMV a fost confirmată prin prezenţa în ser a Ac anti-CMV de tip IgM, motiv pentru care a fost instituit tratament antiviral.
În ciuda suportului funcţiilor vitale, a tratamentului antiviral, evoluţia pacientei rămâne critică și se complică prin apariţia de fistulă anastomotică, evidenţiată prin apariţia de drenaj cu aspect bilios de la nivelul hemitoracelui drept. Familia pacientei refuză reintervenţia.
Starea pacientei se agravează și evoluează spre deces în ziua a 10-a după prima reintervenţie.
Discuţii:
Membru al familiei Herpesviridae, citomegalovirusul (CMV) poate afecta persoane de orice vârstă și deseori infecţia este asimptomatică[1, 2]. Tubul digestiv este unul dintre cele mai frecvent implicate sisteme de organe, iar in aproape o treime din cazuri infecţia este asociată cu leziuni tisulare[3]
Diagnosticul de boala gastro-intestinală datorată CMV se stabilește prin prezenţa simptomelor, punerea în evidenţă a leziunilor mucoase și confirmarea prezenţei CMV histopatologic, imunohistochimic (IHC) cu anticorpi monoclonali anti-CMV, prin izolarea CMV sau prin tehnici de hibridizare a AND-ului[4], tehnicile IHC prezentând o sensibilitate și specificitate mai mare, comparativ cu examnul HP prin coloraţiile standard[5, 6] .
Considerată clasic afecţiune a persoanelor imunocompromise, CMV poate infecta și persoane cu status imunologic normal[7, 8, 9]. Vârsta înaintată, stările critice, diabetul zaharat, boala cronică de rinichi, neoplazia (în special cea hematologică), tratamentul corticosteroid pot fi consideraţi factori favorizanţi pentru imunodepresie și, respectiv, pentru infecţie cu CMV[9, 10]
Leziunile la nivelul tractului digestiv nu au caracter de specificitate, diferitele grade de inflamaţie și ulceraţii fiind principalele tipuri de leziuni evidenţiate endoscopic[10, 11, 12]. Chiar dacă serologia ne poate orienta în diagnostic, aceasta nu se efectuează de rutină și nu se corelează cu
severitatea bolii, fiind necesară confirmarea HP.
Hipoalbuminemia[8], trombocitopenia și hemoragia digestivă sunt factori de prognostic negative pentru mortalitatea intra-spitalicească[13].
Simptomatologia diferă în funcţie de localizare (cea colonică fiind considerată cea mai frecventă) și severitatea bolii. Pacienţii simptomatici acuză disfagie sau odinofagie, durere epigastrică (în localizările esofagiene), greaţă și vărsături, durere abdominală, scădere ponderală în localizările gastro-duodenale[14, 15]
Dezvoltarea unui neoplasm gastric pe un substrat inflamator cronic determinat de infecţia cu CMV asociată cu prezenţa H. pylori a fost sugerată de studiul lui M. Ueno[16]
Administrarea tratamentului antiviral (Ganciclovir) este recomandată pentru cel puţin 2-3 săptămâni, cu posibilitatea prelungirii în cazuri selecţionate, forma secvenţială de tratament (administrare i.v. urmată de administrare p.o.) fiind cea mai frecventă. Reducerea dozelor de preparate imunosupresoare precum și suportul nutrițional sunt elemente-cheie în obţinerea unui rezultat favorabil.
Concluzii:
Patologiile digestive de etiologie virală nu au caractere specifice și pot mima afecţiunile non-infecţioase și neoplazice, întârziind iniţierea tratamentului ţintit (antiviral) și afectând negativ evoluţia pacienţilor.
Căutarea activă a substratului infecţios (mai ales la persoanele imunocompromise, dar nu numai) este esenţială. Întârzierea tratamentului specific poate duce la apariţia complicaţiilor locale și dezvoltarea neoplaziilor.
Bibliografie:
1. Fakhreddine A.Y., Frenette C.T., Konijeti G.G. A practical review of cytomegalovirus in gastroenterology and hepatology. Gastroenterol. Res. Pract. 2019;2019:6156581. doi: 10.1155/2019/6156581.
2. You D.M., Johnson M.D. Cytomegalovirus infection and the gastrointestinal tract. Curr. Gastroenterol. Rep. 2012;14:334–342. doi: 10.1007/s11894-012-0266-4.
3. Rafailidis P.I., Mourtzoukou E.G., Varbobitis I.C., Falagas M.E. Severe cytomegalovirus infection in apparently immunocompetent patients: A systematic review. Virol. J. 2008;5:47. doi: 10.1186/1743-422X-5-47.
4. Ljungman P., Boeckh M., Hirsch H.H., Josephson F., Lundgren J., Nichols G., Pikis A., Razonable R.R., Miller V., Griffiths P.D. Definitions of cytomegalovirus infection and disease in transplant patients for use in
clinical trials. Clin. Infect. Dis. 2016;64:87–91. doi: 10.1093/cid/ciw668.
5. Ross S.A., Novak Z., Pati S., Boppana S.B. Overview of the diagnosis of cytomegalovirus infection. Infect. Disord.-Drug Targets. 2011;11:466–474. doi: 10.2174/187152611797636703.
6. Liao X., Reed S.L., Lin G.Y. Immunostaining detection of cytomegalovirus in gastrointestinal biopsies: Clinicopathological correlation at a large academic health system. Gastroenterol. Res. 2016;9:92–98. doi: 10.14740/gr725e
7. Wetwittayakhlang P., Rujeerapaiboon N., Wetwittayakhlung P., Sripongpun P., Pruphetkaew N., Jandee S., Chamroonkul N., Piratvisuth T. Clinical features, endoscopic findings, and predictive factors for mortality in tissue-invasive gastrointestinal cytomegalovirus disease between immunocompetent and immunocompromised patients. Gastroenterol. Res. Pract. 2021;2021:8886525. doi: 10.1155/2021/8886525.
8. Chaemsupaphan T., Limsrivilai J., Thongdee C., Sudcharoen A., Pongpaibul A., Pausawasdi N., Charatcharoenwitthaya P. Patient characteristics, clinical manifestations, prognosis, and factors associated with gastrointestinal cytomegalovirus infection in immunocompetent patients. BMC Gastroenterol. 2020;20:22. doi: 10.1186/s12876-020-1174-y.
9. Marques S., Carmo J., Pinto D., Bispo M., Ramos S., Chagas C. Cytomegalovirus disease of the upper gastrointestinal tract: A 10-year retrospective study. GE Port. J. Gastroenterol. 2017;24:262–268. doi: 10.1159/000479232.
10. Yoon J., Lee J., Kim D.S., Lee J.W., Hong S.W., Hwang H.W., Hwang S.W., Park S.H., Yang D.-H., Ye B.D., et al. Endoscopic features and clinical outcomes of cytomegalovirus gastroenterocolitis in immunocompetent patients. Sci. Rep. 2021;11:6284. doi: 10.1038/ s41598-021-85845-8.
11. Le P.-H., Kuo C.-J., Wu R.-C., Hsu J.-T., Su M.-Y., Lin C.J., Chiu C.-T. Pancolitis associated with higher mortality risk of cytomegalovirus colitis in patients without inflammatory bowel disease. Ther. Clin. Risk Manag. 2018;14:1445–1451. doi: 10.2147/TCRM.S172071.
12. Lee J.S., Yun J., Ham S., Park H., Lee H., Kim J., Byeon J.-S., Jung H.-Y., Kim N., Kim D.H. Machine learning approach for differentiating cytomegalovirus esophagitis from herpes simplex virus esophagitis. Sci. Rep. 2021;11:3672. doi: 10.1038/s41598-020-78556-z.
13. Lee J.S., Yun J., Ham S., Park H., Lee H., Kim J., Byeon J.-S., Jung H.-Y., Kim N., Kim D.H. Machine learning approach for differentiating cytomegalovirus esophagitis from herpes simplex virus esophagitis. Sci. Rep. 2021;11:3672. doi: 10.1038/s41598-020-78556-z.
14. Wang HW, Kuo CJ, Lin WR, et al: The clinical characteristics and manifestations of cytomegalovirus esophagitis. Dis Esophagus 2016;29:392-399.
15. You DM, Johnson MD: Cytomegalovirus infection and the gastrointestinal tract. Curr Gastroenterol Rep 2012;14:334-342.
16. Ueno M, Shimodate Y, Yamamoto S, Yamamoto H, Mizuno M. Gastric cancer associated with refractory cytomegalovirus gastritis. Clin J Gastroenterol. 2017 Dec;10(6):498-502. doi: 10.1007/s12328-017-07739. Epub 2017 Sep 7. PMID: 28884453.
70 www.revistamedicalmarket.ro
Oncologie
Articole de specialitate



































































 Scanați pentru kit-ul complet!
Scanați pentru kit-ul complet!




















































































 PENTRU MAI MULTE DETALII SCANEAZA AICI
PENTRU MAI MULTE DETALII SCANEAZA AICI

7 zile după radioterapie. Începerea tratamentului cu StrataXRT
După 72h de tratament cu StrataXRT După 10 zile de tratament cu StrataXRT
Sesiunea 17 de radioterapie.
Începerea tratamentului cu StrataXRT
Sesiunea 26 de radioterapie.
După 14 zile de tratament cu StrataXRT
7 zile după radioterapie. Începerea tratamentului cu StrataXRT
După 72h de tratament cu StrataXRT După 10 zile de tratament cu StrataXRT
Sesiunea 17 de radioterapie.
Începerea tratamentului cu StrataXRT
Sesiunea 26 de radioterapie.
După 14 zile de tratament cu StrataXRT





















































